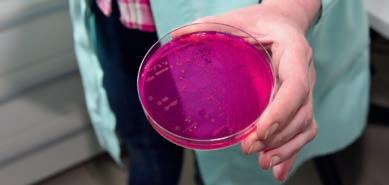

The 51st Western European Fish Technologists Association (WEFTA) Conference will take place in Copenhagen, Denmark from 16th-20th October 2023.
WEFTA is the central platform in Europe for institutions engaged in fish processing, applied food science, aquaculture, seafood technology, health effects of seafood consumption and consumer studies. WEFTA aims at improving safety and quality of seafood on and from the European and other markets through research within this area. Research activities of the WEFTA institutes are coordinated to the benefit of research institutes, the fishery industry, consumers, stakeholders and governments. The annual WEFTA conference is a valuable occasion for scientists, students and the seafood industry to meet and present recent research achievements and to share experience. Besides, the conference constitutes an outstanding forum for discussions and networking.
WEFTA consists of 17 European universities and organisations within fisheries and aquaculture research
in Europe (Belgium, Poland, Finland, Croatia, Denmark, France, Germany, Greece, Iceland, Ireland, Italy, Netherlands, Norway, Portugal, Spain, Sweden and Türkiye).
The theme for this year’s conference is: Sustainable utilization of aquatic resources – changing the way we Seafood. Through the following topics, we intend to broaden our knowledge and thus the way we Seafood. All aspects of fish technology, which lead to sustainable utilization of aquatic resources, can affect the way we Seafood.
The topics will be:
• Sustainable aquaculture and its link to seafood quality
• Micro-/macroalgae and its applications in food
• Side streams for food and non-food products to reach zero waste production
• Processing and quality of seafood
• Safety and authenticity
• Consumer attitudes, societal challenges and seafood products



Much of the seafood consumed in the EU is farmed, but only 10 of it is produced in the bloc. Over the last three decades production from EU aquaculture has grown far slower than farmed seafood output in other parts of the world, and policy makers want that to change. e Lithuanian aquaculture strategic plan to increase production focuses on four objectives: increase resilience and competitiveness, play a part in the green transition, engage with consumers to provide information and generate acceptance, and bring about development and innovation. e strategy is being implemented with support from the European Maritime and Fisheries Fund. More recirculation aquaculture systems growing high value species like African cat sh, rainbow trout, and eel, and more e cient pond farming of common carp and other species in polyculture will allow Lithuania to almost double both volume and value of farmed sh and seafood. e plan foresees the expansion of organic sh production as well. e envisaged boost in aquaculture production in Lithuania may hold useful lessons for other countries as well. Read more from page 24
Micro- and macroalgae are the focus of a growing industry to exploit the nutritional and other important components that these organisms o er. A new project, AlgaeProBANOS, will accelerate algae product development and bring sustainable algae solutions to European markets. e project’s 26 partners will focus on the sustainability and circularity of products from micro and macroalgae while meeting industry’s quality and quantity needs. e four-year project will develop eight new products targeting various markets including food, feed, cosmetics, and nutraceuticals. It will also develop digital tools to assist producers throughout the algae production process, to draw connections between producers and investors, and to o er support to entrepreneurs. e AlgaeProBANOS project will utilise a variety of diverse and innovative approaches to transform Europe’s algae sector in the years to come. Read more on page 46
Trout farming creates environments that are susceptible to infectious disease outbreaks. High population densities, poor environmental conditions, husbandry practices, or hygiene all increase stress in sh. Stress impacts sh immune systems, making them more susceptible to disease. Outbreaks in trout farms threaten stock populations and can cause economic losses for producers. Even isolated systems like recirculation systems (RAS) are at risk of disease outbreak. No matter the production technology, early recognition of an outbreak is crucial to prevent damage to sh stocks and economic losses. To minimise disease outbreaks in trout farms, there are a variety of precautions that producers and regulators take. In farms, the oxygen content and temperature of the water can be closely monitored to enhance biosecurity. Other mitigation strategies include vaccinations, functional feeds, probiotics, postbiotics, but for many farmers it is unclear which of these products are e ective. e EU Animal Health Law, which went into e ect in April 2021 has put measures in place to o er information to sh farmers with clear, streamlined content to clarify these ambiguities. Read Dr Manfred Klinkhardt’s article on page 50
Consumers are becoming increasingly aware of what they eat and how it is produced. ey are concerned about the impact food has on the individual and on the planet, and they seek reassurance that food products meet certain standards. Among the many standards to which companies can choose to be certi ed are those developed by GLOBALG.A.P. eirs is a farm assurance programme that ensures safe, responsible, and transparent practices in the production of fruits and vegetables, owers, and farmed sh and seafood. e organisation was founded in response to food security concerns and has expanded to regulate farming practices globally. Standards cover both aquaculture and feed products, ensuring best practices are deployed in feed mills through hatcheries to grow-out and post-harvest. e organization uses a universal label, the GGN label, to enhance transparency and inform consumers about certi ed products. One of the important features of the GLOBALG.A.P. standard is the emphasis placed on animal welfare, something that resonates particularly well with today’s consumers. Read more on page 55














14 International Carp Conference, 31 August to 1 September 2023, Szarvas, Hungary
Farming carps is a rich source of ecosystem benefits
15 Aquaculture Europe 2023, 18-21 September 2023, Vienna


Balance diversity to account for area specificities
17 DanFish International, 10-12 October 2023, Aalborg
Visitors from all over the world set course for Aalborg
18 Conxemar exhibition and Conxemar-FAO Congress, 2-5 October 2023, Vigo, Spain
Rethinking the seafood value chain in a sustainable way
19 International aquaculture conference in Bucharest fosters collaboration among stakeholders
Efficient and sustainable European aquaculture
21 Seafood Expo Global, Seafood Processing Global, 25-27 April 2023, Barcelona
The biggest show ever




24 The aquaculture sector in Lithuania
Strategic plan with ambitious targets

28 Lithuanian presidency of Baltfish enabled members to reach important compromises
A collaborative forum shapes EU fisheries legislation in the Baltic

29 Farmed in the EU programme promotes aquaculture among school pupils
Success leads to repeated renewals
32 Fish & Fish believes farming eels is the way to rehabilitate stocks
Raising eels for sale and restocking
35 ICECO Fish specialises in salmon and herring products for the overseas and domestic markets Every effort goes into ensuring quality
38 Lithuania’s National Food and Veterinary Risk Assessment Institute
Multiple benefits from free testing of farmed fish
41 Akvapona expands production of catfish as demand explodes New facility to produce 1,000 tonnes by next year
43 Sustainable alternative to antibiotics to fight diseases in trout farming
Bacteriophages could reduce antibiotic use
44 Mission Ocean: A multi-layered initiative to restore ocean health
EU project to rescue and protect oceans
46 Sustainable and innovative algae products: Bridging the gap to a circular economy
The EU pioneers the transformation of the algae market
Ukraine
48 Ukraine’s seafood business: Impacts of Russia’s war against Ukraine
Fish, love, and war
50 Proactive management reduces health risks in trout farming Economic success through healthy fish
Certification
55 GLOBALG.A.P. ensures safe, responsible and transparent practices throughout the production process Certifying producers in the aquaculture sector
57 Raisioaqua, Finland’s only fish feed factory, now operates as Alltech Fennoaqua Oy
Securing aquaculture production in Finland

58 SAIREM microwave and radio frequency solutions—each have their own strengths
Tempering machines that save time and money
60 Cretel designs and manufactures fish processing equipment and washing and drying systems
New fish skinners tick all the right boxes
GuestPages:TatjanaHema
62 The UNEP/MAP-Barcelona Convention system

A legal framework for a healthier Mediterranean
54 Fish Infonetwork News
65 Diary Dates
66 Imprint,













Addressing the problems of misreporting of catches, illegal discards of unwanted catches, and other activities that hinder efforts to achieve sustainable fishing levels, the European Council and the European Parliament have reached agreement on a set of updates to the rules governing fishing in EU waters set out in the Common Fisheries Policy. Overfishing endangers both the long-term sustainability of the marine environment and the livelihoods of the fishermen and coastal communities that rely on it.
The agreement updates around 70 of existing rules on fishing practices. For example:
— All vessels will be required to use vessel monitoring systems (VMS) and electronic recording of catches (with a
multiyear grace period for certain smaller vessels)
— Recreational fishers will also be required to electronically record their catches of certain species
— Improvements will be made in traceability of fresh fishery and aquaculture products along the supply chain
— Certain larger vessels will be equipped with devices to measure engine power to stay within CFP limits.
To help limit or avoid misreporting of catches, intentional or not, in commercial and recreational fisheries, new rules will be placed on the margin of error tolerance when estimating catches. The new rules go into effect 2-4 years after their adoption, allowing time for adjustment by commercial and recreational stakeholders.
Average per capita seafood consumption in the EU is estimated at 24.4 kg a year, of which 75% comes from wild fisheries.
A conference at the recent Seafood Expo Global 2023 in April, entitled “Get More Value From Your Seafood Side-Stream,” and organized by Food & BioCluster Denmark, attracted about 75 fishery and aquaculture industry representatives to discuss different solutions for a more sustainable and valuable utilization of “side-streams,” or secondary products, from processing fish and shellfish. In these troubled times for the seafood industry, it is important to cut waste when possible. Gone are the days when fish were cut only for their flesh, and maybe the remains went for meal and oil processing. Today, fish guts go into pharmaceuticals, fish skins make an array of edible or industrial products, and even
the water left over from boiling shellfish is valuable as flavouring for other dishes.
The conference organizer and several other organizations participating in the conference are part of an EU-funded project called WaSeaBi, backed by 13 organizations from Denmark, Sweden, Spain, and Belgium, that focusses on seafood side-stream optimization from all sides, technological and economical. The project’s chair, Charlotte Jacobsen from the Technical University of Denmark, says that to feed 10 billion people by 2050 we must make better use of the sea’s resources, including efficient and sustainable supply systems for bycatch and side-streams
WaSeaBi is a four-year project where the goal is to optimize the utilization of side streams from aquaculture, fishing and the fishing industry by developing new methods for producing ingredients for the food industry.
from the fishing industry. The best way to do this within the industry is to make it profitable to do so, which requires among other things, imagination. (Using water from steaming lobsters, as a small example.) As much as 70 of a fish, Jacobsen says, ends up as low-value product, when more valuable products can be envisioned, such as bioactive peptides from hake bycatch,
flavorings from salmon, aromatic substances from cod, flavorings from mussel boiling water, protein and phosphorus from cod brine, flavorings from salmon and cod that can be used as ingredients in the food industry, and minced fish meat for herring burgers made from the part of the herring that normally remains on the backbone after the rest of the fillet has been cut out.
Eurofish



While about 80 of marine plastic pollution originates from land, the remaining, yet still significant, 20 comes from water-based human activity, including fishing, shipping, and tourism. It has been estimated that almost onethird of water-based plastic pollution consists of fishnets, traps and longlines, commonly known as ALDFGs (Abandoned, Lost, or otherwise Discarded Fishing Gear) or fishing gear components. The UN is pursuing a legally binding plastic treaty to curb this pollution threat.
UN Resolution 5/14, “End plastic pollution: Towards an international legally binding instrument,” was adopted on 2 March 2022, and further UN action continues, not to “end” plastic use but to further incorporate plastic in the circular economy through better product designs, waste management, and recycling systems.
Recently, the Commission received advice on the treaty from the North Sea Advisory Council, an assembly of fishing interests (60 of total assembly members) and other stakeholders (40). NSAC noted its motivation to offer advice is the fact that fishermen are the
Plastic pollution is one of the great environmental challenges of the 21st century, causing wide-ranging damage to ecosystems and human health, while the fossil-fuel origins of most of the plastics produced have implications for climate change, reports the OECD.
largest group of stakeholders that profit directly from a healthy sea. As an expression of its commitment NSAC explained initiatives it and its members have already undertaken to protect the North Sea, including, among others:
— Fishing for Litter: An awardwinning project launched by OSPAR where fishers volunteer to bring back to land any marine litter collected in their daily activities.
— Port Reception Facilities (PRF) Directive: A fundamental infrastructure for initiatives such as Fishing for Litter which provides facilities on land to collect and sort the different materials collected offshore.
— TEFIBIO: The goal of the EMFFfunded project is to find an alternative for nylon on fishing nets, one that can be compostable and degradable without turning into microplastics.
NSAC stressed that much more is needed, because these efforts are either voluntary or funded by shortterm contracts. Further, the Treaty will need to recognize regional and species-specific differences within the broader fishing “industry” and to design its binding rules to be flexible enough to accommodate those differences, by setting minimum standards while ensuring a level playing field across the diverse array of vessels that ply the North Sea.
A bipartisan effort has been made to promote offshore aquaculture production in America via legislation reintroduced to the Senate in a bill craftily named “Advancing the Quality and Understanding of American Aquaculture” or AQUAA. The bill seeks to encourage sustainable seafood farming in federal waters (starting at state boundaries of 3 miles from shore for most states to the 12-mile federal
territorial limit and beyond to the EEZ boundary) by standardising the permitting processes and the standards for production methods. Currently, U.S. fisheries and aquaculture in general fall under both major agencies’ purview, mainly according to whether the waters are inland (multiple agencies within the Department of Agriculture) or marine (National Oceanic and Atmospheric Administration,
part of the Department of Commerce), but there are significant complicating overlaps. The bill seeks to harmonise important rules and regulations and combine promotional and supportive efforts.
Among other provisions, the AQUAA Act would:
— Uphold existing environmental standards while providing regulatory clarity
— Include a set of national standards to guide development of offshore aquaculture
— Include a national plan to identify and establish areas particularly well-suited for aquaculture
— Establish an Office of Marine Aquaculture within NOAA to coordinate federal permits
The AQUAA Act will be accompanied by a companion bill in the House of Representatives soon.
Since 1977, a barter deal has allowed Russian vessels to transship their catch at Faroese ports in exchange for catch quotas for Faroese boats in Russian waters. The deal has allowed activity in blue whiting in or near Faroe waters and cod in the Barents Sea, as well as vessel repair and
maintenance work in Faroe shipyards. With the invasion of Ukraine, however, many Faroese citizens and politicians of all political stripes favor restricting or ending altogether this system with Russia. The Faroe Government has proposed restricting the volume of Russian-harvested
fish from 400,000 tonnes annually in recent years to 100,000 tonnes per year and ending nonemergency vessel repair work in Faroese shipyards. Recent developments have led to investigations of Russian fishing vessels, revealing that some do no fishing, or have equipment inconsistent
with a fishing vessel, while in Faroese waters. Thus, proposed changes include specifying which individual Russian vessels can have continued access to Faroese waters and ports. A government decision on modifying or ending the longstanding agreement is expected in the autumn.

Since records began in 1956, Japanese production of wild-caught and farmed fish and shellfish reached their lowest level in 2022, a decline attributed mainly to long-term warming waters as well as to overfishing, stated the Japanese Ministry of Agriculture,
Forestry and Fisheries in an annual report. The report, describing a second consecutive year of decline in major species output, said the poor performance of the fishery and aquaculture sectors is likely to continue for many years, due to rising sea temperatures.
Production dropped to record lows for saury, flying squid, and octopus in 2022. Other species which dropped included sardine, mackerel, and farmed eel. Not all species suffered falloffs in 2022—increases were registered for wild salmon and
anchovy, and for farmed scallops. Fishery managers will work to tighten and improve regulations designed to prevent overfishing, and will raise the number of regulated species to around 200 from the recent 50 by the end of the current fiscal year.
New data from Estonia’s Department of Statistics show that sales volume of farmed fish fell to 801 tonnes in 2022, down by 50 tonnes in 2021 and the third yearly decline in a row. The average sales price rose to 6 euros per kg in 2022, up from 5 euros per kg a year earlier, and nearly double the average price three years ago. Rainbow trout remains the most farmed and traded fish in Estonia, accounting for 85 of the country’s total farmed fish volume. Trout caviar output reached 2,7 tonnes in 2022, down sharply from the previous year, and the lowest volume in a decade. However, the average price of fish caviar grew by 50 from a year earlier. Crayfish output totaled 0,6 tonnes, down from a 2009 peak of 2,0 tonnes. Besides trout, species produced by Estonian aquaculture include tench, eel, African catfish, carp, common catfish, sturgeon (Siberian and Russian sturgeon), and grass carp.
Estonia’s production from capture fisheries and aquaculture alone is on average three times higher than the annual consumption of fish and seafood. Marinated, salted, and smoked fish and seafood in an Estonian supermarket.


The Danish Parliament has approved a plan for a massive expansion of offshore wind generation of nine gigawatts by the year 2030. The locations of the necessary new wind turbines and their connecting underwater cables will directly impact Danish fishermen because these locations are generally off-limits to fishing activity, say the Danish Fishermen Producers Organization (DFPO) and the Danish Fisheries Association (DFA), both representing commercial fishing interests. Without disputing that there is a growing need for sustainable energy production, the fishing industry is determined to become more involved in the decision-making process regarding turbine location
so that fishing and electricity generation can coexist. The DFA notes that, according to research by Danish Technical University, Danish fishermen today operate on one third of the Danish seabed, with 90 of their catch taken from just under 20 of those waters. Thus, DFA points out, it should be possible to avoid placing turbines on important fishing grounds.
Fishing contributes healthy and climate-friendly food and valuable jobs, says Svend Erik Andersen, DFA chairman, and the Danish government needs to deliver on its promise of coexistence between fishing and offshore turbines. Even restricting fishing over cables should be avoided because, the
association says, fishing vessels have proven they can successfully fish over cables currently in place. Furthermore, with fishing activity occupying a fraction of overall Danish water area, it should be
straightforward to avoid placing new turbines on important fishing grounds. The parliamentary majority also agreed to set aside half a billion kroner for a new ocean foundation, Havfund, to ensure
that the marine environment and fish stocks will not suffer from the expansion of offshore turbines. This must involve fishing industry interests as well, says DFA. “We are happy that our concerns about
the marine environment and fish stocks are being taken care of,” says Andersen, “and the DFA are naturally ready to contribute to the foundation’s work, and we hope that we will be involved.”

After the destruction of Kakhovka Dam on Dnipro River on 6 June 2023 the Kakhovka reservoir has lost 70 of the water volume it stored, flooding cities, villages, agricultural lands, and industrial facilities for hundreds of kilometers downstream, a broad area covering at least 5,000 sq km. Drinking water supplies, sewage pumping stations, and the drainage system of the immense Dnipro River have been obliterated. This, combined with destruction of homes and other buildings and essential infrastructure, has rendered untold numbers of citizens homeless, although to date official deaths have been limited due to Ukraine’s quick responses.
The fisheries sector of Ukraine was particularly hard-hit. The most valuable region for inland fishery and aquaculture is the lower Dnipro before it joins the Black Sea. The dam’s destruction and the resulting flood destroyed more than 100 fish farms covering an area of 1,045 hectares, and that includes only the farms on the unoccupied side bank of the river. No useful information is available from the occupying forces about the destruction of fish farms on the occupied side. Due to a significant drop in the water level, dying fish and other aquatic animals are observed. This situation leads to the irreversible loss of natural populations of aboriginal species of aquatic bioresources that lived in the reservoir, and aquaculture farms were left without water.
Two of the largest Ukrainian fish breeding facilities have been disabled: the Kherson complex



breeding freshwater fish juveniles for the reproduction of native species, and the Dniprovsky complex for sturgeon reproduction. The natural characteristics of the Dnipro River basin have been irrecoverably altered, and any chance of rebuilding the region’s aquaculture sector is completely uncertain. The total immediate environmental damage and financial costs of destruction cannot be estimated because the left bank region is occupied by Russian forces that are not providing information, never mind assistance to those in need. However, it is already obvious that damage to fisheries and aquaculture sectors will extend to the Black Sea’s ecosystem and fish resources.
The flood will completely change the sea’s salinity and water quality as millions of tonnes of fresh water, carrying untold tonnes of pollution from the upstream destruction, flows into the sea. The ruined land left bare after the flood will not recover as drought inevitably hits the region.
Damage to the fisheries sector from the death of only adult fish can amount to 95,000 tonnes or about UAH4 billion.An invasive and readily adaptable algae has taken hold in the Marmara Sea and threatens the Black Sea, scientists report. The seaweed, identified as the genus Caulerpa in the family of green seaweeds, is unique in that an individual consists of a single cell, making it one of the largest single-cell plants in the world. Caulerpa has the nickname “killer algae” because of the speed of adaptation to new environments (limited, however, to tropical and subtropical climates) and the invasive nature of its behavior, given that it has no natural predators. Some scientists believe it may have arrived from the Indo-Pacific region through the Suez Canal, and invaded the Mediterranean and Aegean Seas. In the Marmara Sea it has already displaced native flora,

such as seagrass, limiting their viable range.
The algae Caulerpa can be exterminated, as shown by successful efforts to eradicate it from southern California waters, but only if caught early enough. The spread of invasive species can be attributed to climate change, rising seawater temperatures, increased salinity, pollution, and fishing and shipping activities. Efforts to control or eliminate invasive species include controlling the discharge of ship ballast waters and expanding marine protected areas to limit human activity. The loss of native species such as seagrass can adversely affect marine environment’s whole food chain, including fish and shellfish resources.
Türkiye hosts nine Caulerpa species, of which only two are native while the others are invasive.

World demand for caviar outstrips supply, and prices continue a long-term upward trend. Data for 2022 recently released by API (Italian Fish Farmers Association) show production of caviar from sturgeon and other fish grew to 62 tonnes, around 10 of global supply of 600 tonnes, with rising average prices. This success is likely to continue, given the strict attention paid by Italian fish farmers to species selection, breeding and farming conditions, environmental sustainability, and final product quality. Only China is a larger producer, but Italian farmers assert that the quality of Italian caviar far surpasses the mass-production nature of the Chinese variety.
True caviar comes from several species of sturgeon, which are
endangered in the wild and slow growing on farms. Therefore, such caviar is expensive, but a burgeoning demand for caviar substitutes at more affordable prices is readily met by farmers of trout and several other fish species. The common feature in all this production in Italy is quality control. Italian producers operate strictly under both self-imposed and government monitored quality conditions, ensured a high-grade product while maintaining environmental sustainability and animal welfare. As a result, Italian caviar commands high prices on domestic and, increasingly, international markets. Members of API can rely on past generations of farming experience, as caviar production continues to grow its share of Italy’s famous fishery and aquaculture industry and market.
Some 15 years ago imports of wild sturgeon caviar stopped or nearly stopped worldwide due to CITES restrictions. So, if you plan to spoil yourself a bit with this delicacy, rest assured that 99.9% of it comes from aquaculture.A multi-national workshop
“Aquaculture as a key factor for sustainable food security”, dedicated to supporting Georgia, Moldova, and Ukraine in harmonising their aquaculture approach with EU requirements took place 15-16 June in Brussels. The event was organised by DG NEAR and DG MARE through its Technical Assistance and Information Exchange instrument (TAIEX). The agenda was focused on exchanging good practices for sustainable aquaculture development in order to ensure food security, growth, and employment by developing local aquaculture production and reducing import dependency. Experts from governmental institutions, professional organisations, and scientists from Spain, Romania, Poland, and Hungary shared their experiences with challenges and practical ways of solving them. Good practices were also presented by the stakeholders from the three countries targeted by the workshop. The debates were vivid around the main themes of the aquaculture sector: simplification and improvement
of licensing, capacity-building programmes for farmers, researchers, and decision-makers at both national and regional levels, increasing the participation of aquaculture farmers’ organizations in sector governance and decision-making processes.
European or regional organisations, such as the Fisheries and Aquaculture Monitoring, Evaluation and Local Support Network (FAMENET) and the General Fisheries Commission for the Mediterranean (GFCM), highlighted the importance of cooperation among all actors involved in aquaculture development. One of the main conclusions of the event was that aquaculture holds a strategic importance in providing multiple socio-economic benefits and this significance should be recognized and supported by the national administrations. As shown recently, in the multiple crisis environment of the last years, aquaculture had an active role on the local and regional level in providing food security. It is expected that in
the near future, the EC will work further with the three candidate states and will develop within the TAIEX instrument
tailor-made workshops, expert missions, and study visits for all the topics discussed within the event.
The UK withdrawal from the European Union, known as Brexit, has had widespread negative impacts on many sectors of the British and European economies, including fisheries. The European Commission has devoted large amounts to help mitigate these effects, through a scheme called the Brexit Adjustment Reserve, which operates under EU State aid rules. Recently, a Belgian plan for its fisheries sector was approved for EUR4.5 million in financial aid
to help the sector adjust to the “changed circumstances” resulting from Brexit.
The broad objective of the plan is to “digitalize” the fishing industry, i.e., to move companies to a datadriven business approach using modern data analysis techniques and equipment. Small- and medium-sized active fishing boats with Belgian licenses (flags) will be supported in their modernization investments in amounts
up to EUR64,554 per vessel. This support plan has a EUR4.5 million total budget and a deadline of 31 December 2023.
Industry-specific financial assistance runs under EU State aid rules, which govern how such aid can be provided without causing improper anticompetitive effects. The Commission reviewed Belgium’s fishery sector plan under Article 107(3c) of the EU Treaty on the Functioning of the European
Union which allows countries to support certain activities under certain conditions including, in this case, compatibility with the Common Fisheries Policy, positive effects on sustainability, and at least neutral impacts on company and industry competitiveness. With these boxes checked off, the Commission approved Belgium’s plan to use EU aid to support the fisheries sector’s adjustment to Brexit’s “changed circumstances.”


Cyprinids, which include carps and barbels, are the most farmed species in the world. With 31 million tonnes they represented the main group of species produced in 2021 with a share of 25 percent of the total aquaculture production and a value of USD65 billion. Common carp is seventh among the farmed species in the world with a global production of 4.2m tonnes in 2021 one and a half times more than Atlantic salmon aquaculture production.
Carp farming is one of the most important components of the aquaculture sector with an ancient history. Studies have demonstrated that common carp aquaculture dates back thousand years in Asia and Europe. Common carp is native to the Palearctic region but is today a geographically widespread sh and the source of a multi-billion industry in the world. Outside Asia, Central and Eastern Europe is the region where common carp plays an important role in aquaculture production, especially common carp that can be considered of European heritage.
Pond carp farming means a traditional, extensive production system based on the natural nutrient cycle typical of natural wetland ecosystems. It operates as an open ecological system, where natural and technological processes are built seamlessly on each other. Beyond the direct economic bene ts, the traditional pond aquaculture has diverse and complex socio-economic and environmental bene ts. Pond farming requires low levels of inputs giving high economic resilience; it is strongly integrated
into natural environment and so has a low impact on the environment; moreover, it provides a number of di erent ecosystem services. Carp farming ts well into the FAO’s blue transformation concept. Traditional pond aquaculture also has lessons for the development of circular biobased freshwater farm systems.
e rst International Carp Conference was organised by Polish Farmers Association in Kazimiers Dolny, Poland in 2011. e members of the organising committee come from the most signi cant carp producer countries—Poland, Czech Republic, Hungary, Germany, Romania and Croatia.
e Austrian Lake Fisheries and Aquaculture Association joined
the organisers this year. After the second conference, which also was held in Poland, the organising committee decided that the conference should be held every two years in di erent countries. So the next conferences were held in Vodnany, Czech Republic in 2015, in Zagreb, Croatia in 2017 and the last one in Ansbach, Germany in 2019.
Hungary was selected as the next venue for the conference, however Covid restrictions prevented it from taking place on time. e 6th International Carp Conference, traditionally a two-day event, will now be held in 2023
between 31 August and 1 September in Szarvas, Hungary. e Hungarian co-organisers—Hungarian Fisheries and Aquaculture Inter-branch Association (MAHAL) and the Research Centre for Fisheries and Aquaculture of the Hungarian University of Agriculture and Life Sciences (MATE-HAKI) are proud to host the 6th International Carp Conference. Szarvas is an excellent site for this event. Here, in the valley of the river Körös there has been a long tradition of sheries and pond aquaculture. Common carp has always been the most important sh species in this region and the “Szarvas” carp strains have played an important role in Hungarian sh culture. MATE-HAKI is internationally
acknowledged for its work on the genetic improvement of common carp and the development of carp rearing systems and technologies. e institution partners with the Hungarian Fisheries and Aquaculture Inter-branch Association to promote freshwater aquaculture and its products in Hungary and internationally.
Although the main aim of the carp conferences has not changed signi cantly in the last 12 years—strengthen the “carp segment” within European aquaculture; improve the image

Aquaculture
of carp—the current conference has some speci c features. One of them uses the holistic approach of carp aquaculture to discuss the challenges and opportunities along the whole value chain. Besides considering carp as an important aquatic food, the linkages of carp culture with recreational sheries and restocking of natural waters will also be discussed. e possibility for carp farming to be recognised by international organisations like FAO and UNESCO is also on the agenda. Another important goal is to strengthen the international character of the conference. Europe should increase its contribution to the development
of global carp aquaculture by exploring the opportunities o ered by carp in the Blue Freshwater Bioeconomy. Leaders and key experts from FAO, EIFAAC, FEAP, EATiP and EUROFISH will actively be involved in the programme, and professionals from China and Central Asia will also attend the conference. Opportunities for discussions and dialogues will be provided through thematic panel sessions which will be moderated by acknowledged international aquaculture experts. And scientists will be encouraged to introduce their novel research results in the eld of carp aquaculture in a poster session.
One of the side events of the conference is the 47th MA-HAL Fish Festival that will be held on 2 September at the conference venue in Szarvas. is event o ers an excellent opportunity to taste Hungarian carp dishes paired with wines. After the conference participants can take a guided tour of the HAKI live gene bank and experimental facilities.
Detailed information and online registration form can be found on the conference website: www.carpconferencehungary.com
Bela Halasi-Kovacs, Director, MATE-HAKI
Halasi-Kovacs.Bela@uni-mate.hu
Fish and seafood farming is the most diverse livestock production system in terms of the species cultivated, the production environments and technologies, and levels of intensity. Diversification, however, needs to be balanced against ecosystem fragilities, social responsibility, and the needs of a circular economy.
Ecosystems across the globe are facing threats to biodiversity, and the diversity of food and agricultural systems, for both crops and livestock, is decreasing as well. As the agriculture sector continues to homogenize, its ability to combat other challenges, like climate change and disease, is attenuated. ese topics will be discussed this September, when the European Aquaculture Society (EAS) hosts Aquaculture Europe 2023 in Vienna,
Austria with the theme “Balanced Diversity in Aquaculture Development.”
Aquaculture is distinct from other food systems: both the marine and freshwater sectors are rich with opportunities. Aquaculture has the capacity to provide a signi cant proportion of protein for human consumption if it continues to develop on its current trajectory. Moreover, the aquaculture sector can be developed sustainably, which
will have positive impacts across food systems globally. e aquaculture sector in Europe is growing, if slowly, and diversifying. Production is currently limited to a few dominant species, so to maintain the sector’s positive trends, it is crucial that it continues to diversify. Trends suggest
that diversi cation, the allocation of key resources, and the utilization of circular economy principles will contribute to growth in the aquaculture sectors in Europe, where production is currently relatively low. To take stock and to see what the future holds, the European
Aquaculture Society (EAS) will focus the 2023 Aquaculture Europe Conference on balancing diversity in aquaculture development. e sector is conscious of the importance of balancing, and not rushing, diversi cation. Emphasis is therefore placed on making diversi cation plans keeping local environments in mind, so as not to place undue stress upon natural resources, existing social arrangements, markets, and other pre-existing structures that could possibly be a ected by the diversi cation of the sector.
e Aquaculture Europe conference will include an international trade expo at which companies can display their products and services, all of which will relate to the aquaculture sector. e conference will also consist of a variety of panels, forums, and sessions all focused on many of the latest industry developments. Students can also attend the conference (at a discounted rate) to gather information and build networks within the aquaculture sector. e conference comprises three separate plenary sessions hosted by academics, scientists, and industry professionals who will provide a unique lens on the future of the diversi cation of Europe’s aquaculture sector.
e rst plenary speaker will be József Popp, Professor of Economics and Social Sciences and Dean at Szent István University, Hungary. Professor Popp’s main research is centered around food, energy, and environmental security as well as the food economy, rural development, the supply chain, and renewable



energy. His plenary session will focus on methods for balancing diversity and the responsible use of global resources to produce healthy food. More specically, Professor Popp will discuss aquaculture production methods like intensive-extensive systems, freshwater integrated multitrophic aquaculture (IMTA), and recirculating aquaculture systems and how they can promote diversi cation.
e second plenary session will take place on Wednesday, 20 September, and it will be hosted by Antti Kause and Morten Rye. Dr Kause is a Principal Scientist at the Natural Resources Institute (LUKE) in Finland, and Dr Rye is the Director of External Services at Benchmark Genetics Norway, a world-renowned center for breeding and genomics for aquaculture. During this session the experts will discuss sh breeding programmes and the new instruments developed that contribute to the success of these programmes. ey will address concerns like whether current strains are resilient enough to withstand the changes and challenges sh will face in the short and longer term. ey will also consider the necessary tools, risks, and opportunities in relation to selecting strains that are robust enough to face these challenges.
e third and nal plenary session will be hosted by Lissy Smit, the CEO of Aqua Spark on ursday, 21 September. Aqua Spark is an investment fund that invests in new, innovative, and sustainable solutions for the aquaculture sector’s most pressing challenges. eir investments range across the entire chain of industry. As
an investor, Ms Smit will provide a unique perspective, and she will discuss the ways in which investors like Aqua Spark are seeking investment opportunities that contribute to the development of the aquaculture sector to ensure that the process is healthy, environmentally conscious, and provides a ordable sh. She will discuss her company’s current portfolio to provide insight into solutions that started as ideas in an academic setting and were then scaled up. e hope is that these plenary sessions will provide attendees with a comprehensive understanding of the importance of diversity for the future of the aquaculture industry.
 Nora Goodman, Euro sh, nora@euro sh.dk
Nora Goodman, Euro sh, nora@euro sh.dk
For more information, contact European Aquaculture Society Slijkensesteenweg 4 Oostende
B-8400
BELGIUM
Tel.: +32 59 32 38 59
https://aquaeas.eu/
AE2023 Contacts:
Conference: ae2023@aquaeas.eu
Registration: worldaqua@was.org
Booths/Sponsors: mario @marevent.com
József Popp, Professor of Economics and Social Sciences and Dean at Szent István University, Hungary Antti Kause, Principal Scientist, Natural Resources Institute (LUKE), Finland Morten Rye, Director, External Services, Benchmark Genetics Norway Lissy Smit, CEO, Aqua Spark, NetherlandsDanFish International, 10-12 October 2023, Aalborg
This October, Aalborg Congress & Culture Center (AKKC) welcomes over 12,000 visitors from around the world. Fishermen, skippers, engineers, naval architects, among many others, make the pilgrimage to the Paris of the North to take part in DanFish International, one of the world’s most important fishing fairs.

Held every alternate year, DanFish will open its doors for the 28th time in AKKC with a total oorspace of 24,000 square meters and in an adjacent mobile hall of 4,000 square meters, which, by tradition, is set up in Kildeparken, to make sure there is room for the many exhibitors from home and abroad. e important trade fair attracts visitors from all over the world, including Canada, India, Japan, the USA, France, Norway, and many more countries.
DanFish International provides a perfect ground for concluding a large number of contracts after the fair, but there are also more visitors who come to conclude agreements at the fair itself, where, experience shows, deals of a million range are made.
DanFish International is one of the world’s largest trade fairs for shing equipment, and the trade fair is more relevant than ever, after a few years when trade fair activities throughout the world were postponed or cancelled due to the pandemic. In 2021, the number of visitors to DanFish was also somewhat lower than usual, as countries such as Japan, China, Australia, the USA, and New Zealand were prevented from traveling due to
the corona restrictions. Fortunately, Covid has nally released its grip on the industry, so that many exhibitors and visitors can resume face-to-face contacts across national borders.
Several of the overseas exhibitors who participated in the fair in
2019 were unfortunately forced to stay at home in 2021, due to Covid. Now, fortunately, the representatives of international companies are once again ready to participate in DanFish International, which is a highly welcome development for Else Herfort, AKKC’s Head of Sales & Expos. We sense both among exhibitors and visitors a great interest to participate in the
DanFish show in October without worrying about corona restrictions. Everyone looks forward to coming to the fair, experiencing the atmosphere, and seeing the many products, she says.
For further information about the fair, please contact Ms Herfort at +45 9935 5518, or visit www.dan sh.com.
Fishermen, skippers, engineers, naval architects, and many others come to Aalborg in October to participate in DanFish International. DanFishConxemar exhibition and Conxemar-FAO Congress, 2-5 October 2023, Vigo, Spain

In the first week of October this year, Conxemar, the Spanish Association of Wholesalers, Importers, Exporters and Processors of Fish and Aquaculture Products, is once again organising the Conxemar-FAO Congress and the International Frozen Seafood Products Exhibition. Both events, which in this edition share the Blue Transformation concept, are important national and international meeting points for seafood processing and marketing companies.
The seafood value chain is currently undergoing change, making it essential to rethink how strategies are approached in a complex and volatile environment. In line with this premise, Conxemar and FAO, the United Nations Food and Agriculture Organisation, are once again joining forces to present the 11th Conxemar-FAO International Congress, an event that will focus on the transformation of the entire seafood value chain to achieve a sustainable food system, drawing in all its links and points of view, and in all aspects: social, economic, and environmental.
e all-day congress on 2 October includes a debate on six main themes: blue transformation and the need to rethink the seafood value chain, the importance of brand integrity, the future of shing and its management models, social responsibility in the value chain, business strategies, and traceability and the consumer. National and international producers, retailers, and non-pro t organisations at the forefront of sustainability will discuss pressing issues with experts in science and shery resources in ve round tables.
Some of the confirmed speakers who will be presenting their viewpoints are María Sapiña, Environment Manager of Mercadona; Marcelo Vasconcellos, Fishery Officer of FAO; Andy Hickman, Head of Sea Alliance (Seafish); Marcelo Otero, General Sales Manager of Blumar; Nuno Cosme, Corporate Director of Sustainability CSR of Nueva Pescanova; Emilio Martínez Cadilla, General Manager of Espaderos del Atlántico; and Eduardo Ruiz, Operations Director of Anedilco. Registration for the congress will open soon.
The Conxemar international exhibition is one of the most important in the world, and serves as a meeting point for wholesalers, importers, exporters, processors, manufacturers, distributors, coldstores, and machinery, among other auxiliary services. In 2022, the exhibition drew over 26,000 industry professionals from over a hundred different countries, with more than 700 exhibitors in a total area of
over 37,000 square metres. The 11th Conxemar-FAO Congress will be held on 2 October at the Afundación Vigo headquarters. The 24th International Frozen Seafood Products Trade Exhibition will open its doors from 3 to 5 October at the Vigo Exhibition Institute (IFEVI), and will focus on innovation and sustainability throughout the sector.
For more information: conxemar@conxemar.com www.conxemar.com +34 986 433 351
The Conxemar show highlights the importance of frozen products in the global seafood trade.International aquaculture conference in Bucharest fosters collaboration among stakeholders

Eurofish in collaboration with the National Agency for Fisheries and Aquaculture (NAFA), an institution under the Ministry of Agriculture and Rural Development of Romania, organised the international aquaculture conference, “Salt- and Freshwater Aquaculture in Europe – Sustainable Seafood for the Future” on the 23 and 24 May 2023 in Bucharest. The event was attended by 180 participants from 39 countries, making it the biggest conference in Eurofish’s history.
Representatives from both Euro sh and NAFA spoke on key developments for the sustainable development of the aquaculture sector and potential methods for modernizing the industry to grow uidly with social and environmental change. Participants at the conference had the opportunity to attend presentations from 25 di erent experts. e conference set a precedent for future cooperation and participation from stakeholders across the industry towards the safe, successful, and sustainable development of sheries and aquaculture through Europe.
The conference was inaugurated by Marco Frederiksen, the director of Eurofish, who expressed gratitude to the audience and emphasized the significance of the event as a valuable platform for networking and gaining deeper knowledge about the diverse aspects of aquaculture. He also highlighted the commitment of Eurofish to the subject, highlighting the organization’s involvement in three aquaculture projects, with one of them being coordinated by Eurofish itself. Additionally, he stressed the significance of ongoing research and development efforts in improving
aquaculture practices and promoting sustainability.


Marian Avram, President of the National Agency for Fisheries and Aquaculture (in Romanian ANPA) presented the “Highlights of National Strategy for Fisheries and Aquaculture” which is the Programme for the European Maritime, Fisheries and Aquaculture Fund 20212027. Among the objectives in Romania, President Avram highlighted that fisheries are committed to modernizing fisheries infrastructure, health, safety, and energy efficiency. Objectives in aquaculture are in line with the National Aquaculture Plan where decarbonisation and developing a circular economy are among the priorities. Investments supporting organic, energy efficient, diversified and innovative aquaculture are foreseen as well as compensations for environmental services and new producer organisations and processing facilities. The President of ANPA concluded that the total financial allocation for the Romanian Programme is over EUR232m of which
about EUR162m is funded by the EU.
The Romanian State Secretary, Mihail Cristian Leonov, delivered a speech emphasizing the importance of the event and the aquaculture sector in Romania. He touched upon various
key topics, including the need for animal health research, the development of new models and technologies, and the importance of ensuring food safety. He also highlighted the significance of networks for Romania, the challenges and possibilities associated with the Black
•
www.jpklausen.com
Youronestopsupplierforseafood: Hokiproducts
• NZDory fillets • Once frozenAlaskan Pollock and once frozen PacificCod Mackerel Herring Surimi Base. •••
Please alsodonothesitateto askforspecialties like: NZ Ling fillets • Blue Mackerel • Savorin • Silver Warehou Blue Warehou • • Brotola • Alfonsino • Arrow Squid • Southern BlueWhiting Orange Roughy • Giant Squid
NEW:
Sea region, and the promotion of socio-economic well-being. Additionally, the State Secretary encouraged the exploration of new species in freshwater aquaculture, the emergence of innovative forms of aquaculture, and the integration of competitiveness and training programs to foster the participation and growth of new specialists in the industry.

The conference featured sessions on freshwater and saltwater aquaculture, markets, and certification, with presentations from 25 international and local experts. Christian Philip Unmack, Senior Project Manager at Eurofish, delivered a comprehensive presentation on emerging trends in aquaculture consumption products within the EU. He provided insights into past, current, and future trends, highlighting the potential growth of alternative seafood products like plant-based options and cultivated seafood. Mr Unmack highlighted the pivotal role of data analysis in understanding consumption patterns, driving transformative actions, and facilitating decision-making processes. By leveraging data to identify and
comprehend trends, stakeholders can effectively adapt their practices and strategies to align with the evolving demands of the aquaculture industry. The challenges faced in pond aquaculture and proposed potential solutions were addressed at the conference by Catalin Platon, the president of ROMFISH National Association of Fish Producers. Mr Platon focused on the significance of fish welfare throughout the entire life cycle, highlighting the need for responsible practices. The adoption of circular economy principles and the use of green energy were advocated as important steps towards sustainability. Transparency for fish farmers and the role of associations in creating an investment-friendly environment that attracts the youth were also emphasized.
During his presentation, Tanguy Chever, senior consultant at AND International and member of the EU Market Observatory for Fisheries and Aquaculture products (EUMOFA) shared valuable insights on the organic aquaculture market in the EU. Mr Chever provided attendees with an introduction to EUMOFA and its organic report. He focused on examining the organic production of aquaculture, with speci c attention given
to the signi cant species within the EU market. Among these species, mussels stood out as the main organic option, while the discussion also encompassed carp, a relevant species of interest for the conference attendees from Romania. Mr. Chever also explored the drivers of growth of organic aquaculture, the barriers that need to be addressed, and the potential future expansion within this segment of the sector.
ough speakers came from di erent countries with various backgrounds, many of them shared similar re ections on climate change, growing prices of energy, feed and transportation and other challenges including the importance of innovation, collaboration not only within but also among di erent sectors, as well as good planning and better utilization of “wastes” when a new business is constructed. e shery and aquaculture sector will need to be able to o er better perspectives for the youth to be able to attract new experts and to ensure development in the future as well.
On the second day, participants visited the Nucet Fisheries
Research and Development Station where they saw the experimental centre, with an area of 167 ha consisting of about 90 fish ponds, a pilot station for reproduction and intensive growth of sturgeons and carp species in intensive and super-intensive systems. The Nucet Aquaculture Research and Development Station is the main supplier of stock material of cultured fish species for fish farms in the south and west of the country.
Overall, the International Aquaculture Conference fostered an environment of knowledgesharing and collaboration. With its unprecedent level of attendance, the two-days discussions emphasized the need for sustainable and responsible aquaculture practices, as well as the importance of innovation and continuous research to drive the industry forward. By addressing key topics, the event has not only achieved great success with valuable insights and opportunities for stakeholders, but it has also provided powerful motivation for even more impactful and inspiring conferences in the future, encouraging stakeholders across Europe to work together towards more sustainable aquaculture.
Eva Kovacs, Euro sh, eva@euro sh.dk
Seafood Expo Global and Seafood Processing Global are arguably the most important events in the seafood world’s calendar. Held in parallel at the Fira de Barcelona exhibition grounds, the events cater to companies along the entire seafood supply chain and to the manufacturers of equipment and providers of services to the industry.
This year the events were bigger than ever, occupying almost 50,000 square meters of space or a fth more than the previous largest edition (in 2019) and almost a quarter more than in 2022 which was the rst year the event was held in Barcelona. Occupying this area were 89 regional and national pavilions and 2,000 companies from 87 countries. Countries from across the globe that were not present last year were represented this
year indicating the international character of the event. Several countries, including Australia, Saudi Arabia, and the Seychelles, were present with pavilions for the rst time while others such as Japan, South Korea, Taiwan, and the US expanded their presence with new regional pavilions, and yet others—China, the Spanish regions of Catalan and Galicia, Portugal and the Netherlands— returned to this edition after a break.






What explains this resurgence of interest in seafood? It is the most highly traded animal protein in the world with a trade value of USD164bn in 2021 or 3.6 times the size of the beef trade and eight times the size of the poultry trade according to Rabobank. e bank forecasts demand for sh to increase by 15 to 183m tonnes
in 2031 compared with 2021. e EU, US, Japan, and China are the biggest markets for seafood and import products from countries around the world, and demand is likely to be driven by increasing awareness of seafood as a healthful and generally sustainable source of protein. According to Rabobank, in the US both the millennial population and the ageing baby boomers are searching for alternatives to traditional proteins and seafood ts the bill.
Specialists in corrosion-resistant, reliable and stable propeller pumps, with high uptime and low energy consumption- for a healthy and sustainable aquaculture.
e growing demand in the US is increasingly being met through imports which increased 55 to USD28bn in 2021 compared with 2013. And demand in the US is projected to continue rising in the long term. e report also points to China as a growing destination for seafood exports. In 2019, Chinese seafood imports reached USD18bn from USD8bn in 2013, an average annual growth of 14.5. And in 2021 imports reached USD17bn, the third highest gure globally. In volume terms, Chinese imports amount to 3m tonnes, the second highest gure in the world. is trend in import growth can be attributed to the decline of the long-distance shing eet and the increasing a uence in Chinese society. e latter creates demand for imported high value products such as shrimp and salmon. e Chinese aquaculture industry is the world’s biggest by a huge margin and it has had success with farming marine species,
but production of farmed marine species cannot compensate for the decline in marine catches. Chinese companies were well represented at the seafood expo. After abandoning its zero-covid policy and allowing travel in to and out of the country China returned to the seafood expo with a vast pavilion.
e 2022 event was the rst to be held in Barcelona and the rst to be held since the pandemic. Part of the seafood industry may have elected to wait and see how the show would develop before committing itself to coming to Barcelona. e show last year was a clear success and rea rmed the need for the industry to meet face to face. It also con rmed that the move to Barcelona and an innovative, contemporary venue was right for the expo providing more growth opportunities, said
Many of the companies that attend Seafood Expo Global are organized into pavilions based on the region they come from. e Galician region of Spain has its own pavilion organized by the Xunta de Galicia. Ramón Damián Fernández Conchas, the Head of Market Service for Xunta de Galicia and Raquel Seijas, Production Manager (Events), Escenoset, who was responsible for the design of the pavilion explained that Escenoset had overseen the design for the Galician pavilion at the show for ten years, even when the show was held in Brussels. e company handles about ten shows

annually, so the show in Barcelona is just one of the many seafood events they work at worldwide, including shows in Europe, the United States, and Asia. Escenoset always works to ensure that the structures it provides are sustainable, so it attempts to fabricate as much as possible with recycled materials. Even the oors are reused from year to year to create as little waste as possible. Materials are recycled from expo to expo whenever possible. Raquel Seijas explained, however, that the designs change every year. is year, the theme created for Xunta de Galicia was “Under the Sea.” e company provides a complete service with the goal to
Liz Plizga, Group Vice President, Diversi ed Communications. e show this year demonstrated categorically that the seafood business is back and that the decision to move to Barcelona has been heartily endorsed by the industry.
A few European companies exhibiting at the show are presented in the following pages; more will
be presented in the next edition of the Euro sh Magazine. ey include sh farmers, processors, service providers, and others up and down the supply chain. e representatives from each of these companies discussed their products, business practices, their e orts towards greater sustainability, and the future they envisage for their companies.
make the expo as seamless as possible. Mr Conchas added that with the help of E, at a recent event in Madrid with over 1,000 companies, Xunta de Galicia won an award for the best stand. e Xunta de Galicia pavilion hosted 38 companies at the Seafood
Expo Global this year. Mr Conchas also noted that an additional 20 Galician companies were exhibiting at the show but did not need to do so under the Xunta de Galicia banner. is shows the strength of the Galician seafood industry, he said.
 Seafood Expo Global in Barcelona has established itself as the definitive hub of the global seafood industry.
Ramón Damián Fernández Conchas, Head of Market Service for Xunta de Galicia, Raquel Seijas, Production Manager (Events), Escenoset
Seafood Expo Global in Barcelona has established itself as the definitive hub of the global seafood industry.
Ramón Damián Fernández Conchas, Head of Market Service for Xunta de Galicia, Raquel Seijas, Production Manager (Events), Escenoset
Mr Velykopolsky founded Fishmaster four years ago in an e ort to provide sh products that consumers might not nd elsewhere in Denmark. Most of his customers moved to Denmark from Ukraine, and Fishmaster tries to replicate access to the products they may have eaten at home. Mr Velykopolsky explained his belief that people feel more at home if they have access to their traditional foods. Herring, for example, is prepared with more sugar in Denmark than in Ukraine, so Fishmaster o ers whole, frozen herring that can be prepared in any traditional way. In addition to frozen herring, they o er salted whole sh and salted lets. ey salt, smoke, and
marinate trout and other sh. All of the production, processing, and smoking is done in-house, by hand; they still need a pinbone-removing machine and won’t have a sh lleting machine until next year. ey have two cars with refrigerators and freezers, and they personally deliver their products throughout Denmark. e company is quite young, and it is still developing.
is year 2023 is the rst year that Fishmaster has attended Seafood Expo Global, and Mr Velykopolskyy reports that even though it is expensive to be present, he has learned a lot from the event about the best methods for packaging and storage. Mr Velykopolskyy was very disappointed that they needed to increase
Pastravaria Busteni is a producer that is a part of the Agricola cooperative in Romania. is ccoperative is made up of ve Romanian aquaculture farmers who collaborate and help one another whenever possible or necessary. Bogdan Mihalache, the company sales manager, says that the company is building two new farms. e rst project, which is well under way, is the construction of a salmon trout farm in a nearby lake in the mountains. e other involves raising trout in the Black Sea, but Mr Mihalache explained that receiving government approval to get this project started has been somewhat of a roadblock. With the project in the mountains alone, the cooperative expects to grow annual production by 500 tonnes within three years.
e market for salmon trout is growing quickly as Romanians appreciate the taste of salmon trout because it has has less fat than salmon, explained Mr Mihalache. e sh will be grown in the lake to 2-3 kilos to cater to the market’s demand for llets. e company has been farming trout in rivers in the mountains for about three years. While it takes 2-3 years to grow sh in the rivers to market size, the sh in the lake will reach this size in about a year because the lake has higher oxygen levels. A variety of tests have ensured the sustainability, cleanliness, and safety of aquaculture in the lake. Since it is in the mountains, temperatures will never get too warm for the sh.
e company is committed to ensuring the water is not polluted; their studies show that sh will consume
Igor Velykopolsky, Founder, Fishmaster, Denmark their prices because of market changes, particularly that of trout caviar one of their main products, the price of which uctuates from year to year. He says that for people who just moved from Ukraine and are unable to buy the sh at retail price, he o ers discounts.
Fishmaster currently only sells to private customers, making deliveries to them twice monthly. He is not as busy as he would wish and is hoping to expand. But he wants to ensure that the company continues to provide the best products in terms of quality, taste, and packaging.
Bogdan Mihalache, Sales Manager, Pastravaria Busteni


any excess feed on the bottom of the lake. e eggs come from di erent hatcheries within the cooperative, and Mr Mihalache speci ed that they will separate the di erent eggs into cages, so they can monitor which sh are healthiest and grow the fastest. Two processing factories already exist in the cooperative and a new factory is planned. e main products are fresh
and smoked sh, but a few valueadded products with vegetables, trufes, and other ingredients are also produced. e sh is sold primarily on the Romanian markets and Mr Mihalache expects that to continue for the foreseeable future.
Nora Goodman, Euro sh, nora@euro sh.dkProduction from fish farming in Lithuania is set to become much bigger over the next seven years as the national strategic plan is implemented. The plan includes measures for production, value addition, sustainability, as well as fish health and welfare among other objectives and should lead to a more competitive and resilient sector.
The EU is one of the largest markets for seafood and among the top traders of sh and seafood products in the world. However, the bloc is heavily dependent on imports of sh and seafood as domestic production is insu cient to meet demand. e 2022 edition of the Fin sh Study1, an annual publication produced by AIPCE-CEP, reckons that the EU’s import dependence on sh and seafood in 2021 was above 65. Since production from capture sheries is at or declining the EU aquaculture sector has a signi cant role to play in reducing the bloc’s dependence on imports by increasing the supply of farmed sh.
Currently, while a quarter of all seafood products consumed in the EU comes from aquaculture, only a tenth comes from domestic production suggesting there is ample scope for growth. Boosting aquaculture production also meets the objectives of other EU initiatives such as the European Green Deal and the Farm to Fork strategy. At the same time, sh farming can contribute to the production of healthful food with a low carbon footprint, generate livelihoods in remote coastal and inland areas, and pioneer
innovative and creative technologies to increase productivity in the sector. However, while aquaculture production in other parts of the world has increased by a factor of four since 1990, in the EU it went up by 11 and declined 8 since 2018, according to the latest STECF report on EU aquaculture2
In a bid to reverse this as well as to achieve the goals mentioned above, in 2021 the EU adopted new strategic guidelines for the aquaculture sector. e guidelines have four overlapping objectives
— building resilience and competitiveness

— participating in the green transition
— ensuring social acceptance and consumer information, and
— increasing knowledge and innovation and include proposals for speci c actions regarding, for example, access to space inland and along coasts, animal welfare, sustainability, and improvements to the regulatory and administrative frameworks. e strategic guidelines have been integrated into countries’ national strategic plans, the implementation of which is supported by the European Maritime and Fisheries Fund (EMFAF) and other funding programmes. A further
instrument, the Aquaculture Assistance Mechanism (AAM), also supports the Member States in the implementation of the strategic guidelines by providing logistical, administrative, and technical assistance. e AAM (https://aquaculture. ec.europa.eu/) is a platform for collecting and sharing information about sustainable aquaculture in the EU, and it develops training and e-learning tools, as well as organising events, and responding to questions from Member States and aquaculture
stakeholders on the guidance documents developed.
Production from the aquaculture sector in Lithuania consists of ponds, tanks and raceways, and recirculation aquaculture systems. While production from ponds has remained largely stable in the ve years to 2022 (though there was a spike in 2021) production from recirculation aquaculture systems (RAS)
in projects that bene t farms by developing closer cooperation between the farmers and scientists, as examples where support from the EMFAF can be expected.
increased more than three times over the same period reaching almost 25 of total aquaculture production in 2022. Output from tanks and raceways accounted for less than 2.5 of the total that year. Production is thus dominated by sh from pond aquaculture and speci cally by common carp which on average accounted for over 70 of total aquaculture production during the last ve years. However, the share of carp production decreased from around 80 in 2018 to 62 in 2022. Another species, African cat sh, accounted for a fth of the production in 2022 up from 6 in 2018. e total value of Lithuanian aquaculture production destined for consumption has risen steadily in the 20182022 period from EUR11 million in 2018 to 18 million in 2022, a 64 increase. e value of African cat sh production (excluding hatcheries and nurseries) shows the greatest development—from EUR0.9 million to EUR3 million (an increase of 233) over the same period. However, the average price for African cat sh in the 2018-2022 period declined from EUR4.23/kg to EUR3.45/kg, mostly due to increased supply and competition.

Lithuania’s multi-annual national strategic plan for the development of sustainable aquaculture for the period 2021 to 2030 has ambitious targets. Production
volume is to almost double from 4,400 tonnes in 2022 to 8,500 tonnes in 2030, while value is to increase to EUR27 million from almost EUR13 million. e investments needed to bring about this growth will be supported by the EMFAF if they are intended to achieve one or more of the objectives mentioned in the national strategic plan. Ieva Zundiene, Director of the Fisheries Department in the Ministry of Agriculture, points to investments in innovative equipment to enhance capacities, modernise and increase e ciency at sh farms, and
Organic aquaculture is also eligible, and the Lithuanian strategic plan foresees production from organic aquaculture reaching 1,200 tonnes in 2030 up from 860 tonnes in 2020. e focus on organic aquaculture is because its responsible use of energy and resources aligns with EU strategies, and the European Commission is therefore encouraging Member States to increase organic production. An action plan to accelerate the development of organic aquaculture was launched in 2021 that emphasises the importance of communicating the bene ts of organic production in the form of high-quality food produced
with lower environmental impacts and higher animal welfare—issues that consumers are increasingly concerned about. e action plan also encourages local and small-scale sh processing to ensure e cient supply chains for organic products. EU promotion campaigns for organic production as well as actions to improve traceability or ght illegal practices are also part of the action plan. Another feature is the promotion of increased use of organic products in public canteens and schools.
Lithuania is among the main producers of organic carp in the EU, but the volumes are relatively small. Currently, however, organic carp is bought from the producers at a lower price than could be expected of organic production or at a similar price to non-organic production, and Ms Zundiene is keen to call a meeting with representatives from the retail sector to discuss why this is the case and what
can be done about it. In general, organic production is foreseen to be compensated at the rate of EUR 0.80 per kilo sold. The idea of the support is to help the farmers with the increased cost of raw inputs and to maintain the price within range of consumers’ budgets. Once consumers get accustomed to eating organic fish and they may be willing to pay for it even if the support is phased out.

Growth in the sector is foreseen to come mainly from RAS systems—to produce more high value species—and from greater productivity from existing pond farms growing sh in polyculture.
No new pond areas are envisaged nor is marine farming in the Baltic Sea being considered due to the already delicate state of its environment. Adaptation and mitigation measures in relation to climate change, the second objective of the strategic guidelines, include measures to reduce pollution, foster innovation, improve energy e ciency and promote the use of sustainable energy. Both sh farming and processing companies are investing in solar power to reduce their dependence on fossil fuels, the price of which shot up last winter. Support from the EMFAF is available for the switch to renewable energy, but most companies will depend on a mix of energy sources as they will not be able to generate enough solar power to cover all their energy needs. Emissions from production and transport are also to
be reduced and the mitigation potential of pond aquaculture is to be better exploited. is method of farming contributes to biodiversity, ood control, and preservation of wetlands among other collateral bene ts. Climate change impacts in the short term can cause loss of production due to extreme weather events such as droughts or oods, the occurrence of algal blooms, and appearance of new pathogens and parasites, states an Aquaculture Advisory Council report3. Global warming, ocean acidi cation, sea level rises, and changes in patterns of precipitation are expected to in uence aquaculture production in the long term. Including adaptation and mitigation measures in the strategic plan is a step towards managing these issues. e report suggests that adaptation to climate change may
also o er opportunities such as diversi cation into lower trophic level species and into integrated multitrophic aquaculture (IMTA). Adaptation strategies could also include improved biosecurity on the farm and selective breeding to add to the resilience of the sector. In terms of mitigation, reductions in greenhouse gas emissions from upstream and downstream activities along the supply chain and in particular the use of lower carbon raw materials for aquafeed will be critical to these e orts.
In keeping with the third objective on social acceptance and consumer information, the plan calls for EU-recognised aquaculture producer organisation (PO) to be established. Among the obligations of these bodies is the creation and implementation of production and marketing schedules, the details of which include how the PO will meet certain goals such as sustainability, traceability, etc. e plan also recommends aquaculture companies and associations to present their products and achievements at international and local exhibitions and fairs. Currently the national sh and aquaculture producers’ association operates as an aquaculture PO in Lithuania implementing a production and marketing plan with the abovementioned tasks.
e plan also mentions control, environmental performance, animal welfare, and knowledge
Strategic plan to be funded through EMFAF, national budget3 Huntington, T (2022). European Aquaculture and Climate Change Adaptation and Mitigation - Advice to the Aquaculture Advisory Council. Final Report produced by Poseidon Aquatic Resources Management Europe Ltd for the AAC. 27 pp plus appendices
and innovation with several measures under each point. For example, developing food quality schemes, breeding sh for restocking of natural water bodies, developing good practices with regard to farming, transport, and slaughter, and promoting the use of innovative technology such as RAS to breed sh are among the measures. ese initiatives as well as those mentioned above will be funded through the EMFAF and the national budget; other funding possibilities include the European Rural Development Fund, the European Regional Development Fund, and the Horizon Europe programme (for research and innovation).
Although aquaculture in Lithuania is still dominated by the production of common carp, output of valuable sh species such as African cat sh, rainbow trout, and eel from RAS systems shows an increasing tendency. Another trend is vertical integration, where farmers invest in processing facilities to add value to their production. Currently about half of the sh producers process their production. Value is added to products by preparing consumer-friendly portions (steaks, llets, portions) packaged in MAP or vacuum thereby
increasing the shelf life. Hot and cold smoking, attractive packaging, quality labels and brands, and sales through supermarket chains or speciality stores also add value to the products. ere is further scope to diversify sources of income by launching catering operations and by direct sales to consumers. Most of the aquaculture production (86 in 2021) is sold on the domestic market while Latvia and Poland are the main export

markets. Exports to Poland have declined with the restrictions on sales of live sh, one of the main export products. Employment in the sector has remained largely stable hovering around 430 employees for the ve years to 2022. ere is, however, a shortage of employees with the specialised skills needed for the sector to develop, such as aquaculture technology engineers and veterinarians specialised in sh diseases. To try and remedy
this, a programme, Farmed in the EU, is introducing the sector to school children that may lead to more of them choosing a career in sh farming. A project o ering free-of-charge testing of farmed sh for diseases at the National Food and Veterinary Risk Assessment Institute will continue for ve years from 2023. Under this project sh farmers can send samples to be tested for a variety of pathogens secure in the knowledge that the results will be kept con dential. e project started with the acquisition of the necessary diagnostic equipment by the institute and while it covers the testing it does not extend to the treatment of the disease, which farmers must defray themselves.
Implementing the provisions of its national strategic plan for aquaculture should create a sustainable, competitive, resilient and diversi ed sector in Lithuania that contributes to nutritional and economic security.

On 1 July 2022 Lithuania started its one-year long presidency of Baltfish, the regional fisheries forum for the Baltic Sea, taking over from Latvia. After a year at the helm the Lithuanians can look back with some satisfaction at the results achieved by the forum.
The history of Balt sh dates back to 2009 when it was started as a agship project within the EU Strategy for the Baltic Sea Region. In December 2013 ministers of the eight Baltic Sea Member States signed a Memorandum of Understanding on the principles and working methods of Balt sh thereby marking the new status of the Balt sh as a permanent sheries forum. e Memorandum stated that the primary goal of Balt sh was to strengthen and improve the Member States coordination and cooperation in sheries management in the Baltic Sea, as well as to develop cooperation with other key stakeholders relevant to Baltic Sea sheries. Balt sh is a forum for exchanging ideas, views, and information to facilitate joint actions and various concrete projects aiming at achieving sustainable sheries in the Baltic Sea Region.
In 2014 the latest reform of the EU common sheries policy (CFP) came into force. One of the key elements introduced with that reform was regionalisation of sheries management within the CFP. e activities of Balt sh have been further developed based on the principles of regionalisation set out
in the Common Fisheries Policy. Regionalisation was introduced to address widespread concerns over the top-down approach in EU sheries management that lacked exibility and adaptation to local and regional realities and failed to consider the diverse conditions throughout EU waters. Balt sh became one of seven groupings of Member States engaged in the process of regionalisation of the EU shery. Under this arrangement Member States with an interest in sheries management are entitled to propose detailed conservation (including technical) measures in joint recommendations, having consulted the relevant Advisory Councils. e measures can be implemented into EU law by the Commission as delegated or implementing acts, on the basis of scienti c, technical and economic advice provided by advisory bodies such as the STECF. Unless the European Parliament or the European Council objects, these acts enter into force.
Lithuania is a devoted and proactive supporter of the CFP’s regional approach and has consistently advocated the balance of environmental, social and economic elements in sheries management.
e situation in the Baltic Sea shery is deteriorating progressively due to a range of environmental and anthropogenic factors, however, it should not be the shers
alone who su er ever-growing pressures and incur the highest price due to various limitations requirements imposed upon them. Each conservation measure should be based on scienti c advice and must be speci c to each site and species. ese are the principles that guide Lithuania—also while holding the Presidency of Balt sh.
Balt sh operates on two levels:
— e high-level group (HLG) comprises the Member States’ sheries directors and invited o cials from the European Commission. Balt sh HLG in accordance with the EU Regulation on the Common Fisheries Policy consults the Baltic Sea advisory Council (BSAC).
— Balt sh Forum Seminar is composed of representatives from Member States, the European Commission and the Baltic Sea Advisory Council (BSAC) as well as representatives from intergovernmental organisations such as ICES, HELCOM, and other relevant stakeholders in the Baltic Sea sheries.
e Balt sh HLG forms its opinion by consensus among its Member States and delivers common positions and joint recommendations. However, a Member State may choose not to join the Balt sh common position or joint recommendation by abstaining.
roughout the Lithuanian Presidency of Balt sh, meetings of the HLG, of technical working
groups with scienti c and technical experts, and of control expert groups were hold on a regular basis. Close contacts with the European Commission and Baltic Sea Advisory Council (BSAC) were also maintained to address the numerous relevant and pressing issues faced by the Baltic Sea sheries sector. Under the Lithuanian presidency intensive work continued on developing new conservation measures to comply with EU environmental obligations, such as further implementing the landing obligation in accordance with the CFP, developing new technical measures to improve selectivity, and establishing area closures. ese measures concern gear selectivity and the at sh shery, as well as the protection of Baltic harbour porpoise, salmon, and Baltic Sea cod.
One of the most important and challenging tasks for every Baltsh Presidency is to nd a compromise on the following year’s
total allowable catches (TACs) and quotas for sh stocks in the Baltic Sea. Under EU law the European Council is responsible for xing and allocating shing opportunities on the basis of a European Commission proposal. Relevant EU Member States’ ministers must reach a political agreement at the Agriculture and Fisheries Council meeting each year. In this process the Council is guided also by the recommendations provided by the Balt sh. For the Balt sh Member States this is a particularly di cult task because of the poor state of part of the commercially exploited sh stocks, as well as diverging priorities and domestic approaches in the di erent Member States.
e Lithuanian presidency gave full priority to the issue of shing opportunities for 2023.
Numerous bilateral meetings were held with the Member States in a bid to facilitate convergence of the di erent positions and to hammer out an agreement between all the Baltic Sea Member States. On the eve of the Agriculture and Fisheries Council meeting, the Balt sh HLG met in Luxemburg. After intense negotiations consensus was achieved over the Balt sh proposal on TACs and quotas for the year 2023. e compromise was reached in line with the scienti c advice provided by ICES and in conformity with the proposal by the European Commission. e stumbling block in this process was the TACs for central Baltic herring and sprat and they were agreed after several hours of negotiations. Balt sh also reached a compromise on some other important elements of the proposal for Council Regulation. It was the rst time in many years that the Balt sh Presidency reached a
compromise among the Baltic Member States before the Council meeting. e outcome of the negotiations was very much welcomed by the Member States and the European Commission, and it greatly facilitated nding a political agreement at the next day’s Council meeting.
e next day, Agriculture and Fisheries ministers reached a political agreement on shing opportunities in the Baltic Sea for 2023 setting the TACs and quota per member state for each species in the Baltic Sea for the coming year in the dedicated Council Regulation. e agreement allowed shing to continue in the Baltic Sea after 1 January 2023 without any disruption despite many challenges, and at the same time contributed to the protection of sh stocks for the future.
Ana Sedenko, Department of Fisheries, Ministry of Agriculture, ana.sedenko@zum.lt
Part of the Farmed in the EU programme is dedicated to promoting the aquaculture sector among school pupils. The idea is to introduce them to the economic, social, and nutritional benefits that stem from this activity.
The Farmed in the EU programme is a comprehensive initiative aimed at promoting sustainable aquaculture and ensuring the production of high-quality food within the European Union. Established with the objective of supporting local sh farmers and fostering food security, this programme has made signi cant strides in enhancing the aquaculture sector‘s sustainability, safety, and e ciency. By adhering to strict regulations and certi cation
processes, Farmed in the EU guarantees that consumers can trust the origin, quality, and environmental standards of the food they consume.
An important aspect of the programme is to promote aquaculture and the consumption of farmed sh to school children. e programme provides young learners and schools with an
introduction to aquaculture, its socio-economic importance, particularly in remote communities, and the bene ts of consuming sustainably farmed seafood. Learning about the sector may also trigger an interest in sh farming and encourage pupils to consider it as a profession when they are older. Activities, projects, and excursions are organised In collaboration with schools that expose the children to sh farming, familiarising them with sh and shell sh and hopefully
inculcating a long-lasting interest in seafood, its commercial and nutritional value. In Lithuania, Gytis Virsilas and a colleague, both from the Rural Business and Markets Development Agency, a body under the Ministry of Agriculture, are responsible for the implementation of the programme. According to Mr Virsilas, Lithuania is only one of a few EU countries that have decided to use this opportunity to promote aquaculture to school pupils. e reason for the limited interest, he
suspects, is the lack of nancial support from the EU to implement the programme. e funding for activities comes instead from the national budget. e EU does, however, provide an overall structure for what the programme should contain, which individual countries can then adapt to re ect their sh farming sectors, since these vary from region to region. In Lithuania, the rst year of the programme drew such an enthusiastic response from the schools that the ministry decided to continue it. is year (2023) will be the fth year that the programme has been implemented.
Schools apply to participate in the programme and are selected based on certain criteria because there is more demand than can be met with the available funding. Each year 50 classes are selected to participate in the programme, half from classes 1 to 4 and the other half from classes 5 to 8. Because the budget has


remained the same, so has the number of classes that can participate despite the increased interest from schools. Schools are chosen depending on whether they have sent their applications in good time and whether they have applied before, among other criteria. Once the schools have been identi ed the pupils are sent some printed material that will help them get the most out of the activities. e material included information about aquaculture in Lithuania, in Europe, and in the world, and about farming technologies. It also contained exercises for the pupils and information for the teachers on how to use the material. e activities include visits by scientists who conduct aquaculture-related classes at the schools for the children. e scientists also introduced the children to the state hatchery where sh are bred for restocking. Here, among other experiences, they could examine the feed the sh were
given and receive a little lecture about its contents and how it was manufactured. Unfortunately, the children could not visit a commercial sh farm as farmers were concerned about the impact of a large group of school children on the health and wellbeing of their stock. It might also have had implications for their customers if the sh fell ill and the farmer could not honour his contracts, a risk they were understandably not willing to run.
To get the most out of the excursion the children were given a brie ng shortly before arrival where they were told what kind of sh they were going to see. At
the state hatchery the children were allowed to feed the sh and observe how they react. ey also got to see all the stages of the sh lifecycle from the larvae to the adult and, best of all, they were allowed to handle the bigger sh. In addition, the children were showed other parts of the system that was used to host the sh, such as the cleaning equipment, the oxygen supply, and ltration modules. Fish behavioural patterns were also explained to the children in simple terms—aggressive behaviour, for example, predation, and cannibalism.
Mr Virsilas explains that his agency organises the entire excursion planning it together with the school since regular lessons are interrupted when the
pupils leave on a trip or when they are taught by the scientists. The agency organises the transport to and from the hatchery or other site and gives instructions to the children en route. They are told where they are going, and why, what they are going to see and do. He makes it a point to ask who among them comes from families that have
Material that was used in the classroom had information about aquaculture in Lithuania. It was put together by Egle Jakubaviciute and Justas Dainys, scientists from the Laboratory of Fish Ecology at the Nature Research Centre who also visited the schools.
something to do with fish either as fishers or as fish farmers. He also asks whether they maintain an aquarium or a small pond with carps. The idea is to establish a rapport with them, make them relax and feel comfortable. Some kids may be seeing a fish or touching a fish for the first time and may not be quite up to it. The agency is also responsible for the instruction the pupils receive at the hatchery, and also the lunch. While part of the objective is to encourage the pupils to eat fish, they are first asked about their preferences and are not compelled to eat fish. Preferences in the group vary with some pupils claiming they eat fish regularly. In fact, Mr Virsilas feels that first showing the children the fish and allowing them to handle specimens and then serving fish for lunch may be a little too much for them. They may associate the fish they are eating with the fish they have played with earlier, which I would like to avoid, so we usually do not offer them fish for lunch. On the other hand, at cooking classes in school the children are taught
about fish dishes and one of the programme-related activities is to make a recipe book that includes recipes using fish. The programme is also used to overcome some children’s antipathy to fish despite not having tried it.


e excursions with the children were sometimes lmed and screened on public television. is often resulted in calls to Mr Virsilas from schools interested in joining the programme, and even from parents trying to nd out how their children could be part of the programme. is positive feedback was among the reasons we decided to continue, says Mr Virsilas, while another was to remedy the continued lack of awareness in Lithuania about the aquaculture sector, the bene ts it brings, and the issues it faces. Among the latter is the lack of specialists needed to develop the sector. e programme seeks to address this by showing the pupils that aquaculture
is a potential career path. For Mr Virsilas the success of the programme lies not only in the interest it generates among parents and schoolteachers, but above all in the reactions of the children when they experience novelties on the excursions and their enthusiasm when they participate in the activities. For the more stone-hearted the programme’s success can be seen in the year-to-year increase in the number of schools that have been applying to participate.
Mr Virsilas draws attention to the fact that children from families that have ed Ukraine are sometimes in the groups. ey receive instructions in Russian, which is sometimes a challenge, so that they too can bene t from the programme. e bigger challenge was during the pandemic when the pupils were expected to maintain distance, wear masks, disinfect their hands regularly, and have their temperature taken which complicated the logistics especially when there were two groups in one day. During lockdowns the children were instructed online which posed its own set of issues as it was completely new way for both pupils and teachers. Some pupils adapted better than others, but in general the results were better when in-person teaching started up again. According to Mr Virsilas, one of the best aspects of the programme was the way that it combined theoretical information imparted in the classroom with practical lessons from the eld where the pupils could reinforce what they had learnt in class. e knowledge they acquire this way stays with them much longer, he feels. If it also leads to more farmed sh consumption and greater interest in aquaculture as a profession, the Farmed in the EU programme would have achieved all its objectives.
A Lithuanian eel farming company, Fish & Fish, produces a variety of value-added eel products that are sold through specialised fish shops in upmarket locations in Lithuanian cities.

The European eel (Anguilla anguilla) has a complex life cycle, migrating thousands of kilometres from freshwater rivers to the Sargasso Sea to spawn. However, due to factors such as over shing, habitat loss, and climate change, the wild eel population has experienced a sharp decline. In response, many European countries have turned to eel farming as a means to meet the demand for eels while reducing pressure on wild stocks.
Eel farming in Europe involves rearing eels from glass eels, which are young eels that have just entered freshwater systems. ese young eels are typically collected from the wild or purchased from specialised suppliers. Once obtained, they are placed in specially designed tanks or ponds and grown to the desired market size.
Fish & Fish, Lithuania’s sole eel farmer, sells mainly live and gutted eels to smokehouses all over Lithuania. We are hoping to do more processing and packaging of our own products and even expand their production to other sh, explained, Martynas Greviskis, the business development manager. After all, we’re called Fish & Fish, so we really should be o ering more than one type of sh, he jests.
Two years ago, in an e ort to make production more e cient and sustainable the company installed
software that helps to manage and track the production and that generates extensive data about their farm. Analysis of the feed and production costs per tank has increased e ciency as a lot has been learned from comparing different feeds and batches. It also allows for traceability. eir sales are primarily in Lithuania with signi cant exports to the Netherlands (live eels) and some to Poland and Latvia. Mr Greviskis explains that there are quotas on how many glass eels can be caught and sold and on how many need to be used for restocking. Farming eels, a process which starts with wild caught glass eels, is inherently sustainable, he argues. If left in the wild it would take thousands of glass eels to yield a single mature eel due to the high mortality rates they su er. As the mature eel prepares to head for the Sargasso Sea to reproduce, it could be caught by a sher. In contrast, glass eels on an eel farm have a survival rate of 97 or 98 and a proportion of them are used for restocking purposes once they have reached a certain size. e places where they are reintroduced into the wild are selected to give them the best chances of growing to maturity and reaching the Sargasso Sea. Fish & Fish therefore releases a portion of its annual eel stock into lakes and rivers to help restore eel populations.
Fish & Fish has developed a number of value-added products from
the eel it produces including gutted and smoked eel, smoked eel llets, smoked eel in jelly, gutted and frozen eel, and frozen eel llets. ese products are sold through specialised delicatessen stores, and a mobile shop that is based close to the entrance of a smart farmers’ market in Vilnius. e original idea was that
the trailer would move from one location to another in the city following a xed schedule. But this turned out to be more complicated than envisaged as all the products had rst to be removed, the risk of damage to the refrigeration units had to be considered, and the trailer was di cult to manoeuvre. e mobile shop
therefore is kept at this location over weekends, when people do their shopping. ere are, of course, costs associated with having the trailer in the form of rent and electricity charges which must be considered. However, the decision to have the trailer was not based solely on a cost-bene t analysis as there are sometimes bene ts that are di cult to place a value on. Sales from the trailer are not huge, but because of the trailer’s presence, Mr Greviskis started getting calls from some big companies that were interested in the products he was selling. Having the trailer here is like a giant advertisement for us, he says.
When another shop selling similar products at the site closed, Mr Greviskis spied an opportunity. He entered into a collaboration with a farmer and processor of sturgeon, carp, and trout. is is a pilot project, says Mr Greviskis, to see if a wider assortment of products will draw more customers to the shop. If it works well, he will consider collaborating with other

producers. Shops that specialise in sh products are not common and when they exist, they tend to focus on products based on imported marine sh. Mr Greviskis’ idea is to have a delicatessen sh store promoting high quality items processed from domestically produced freshwater sh.

Fish & Fish is a member of the Lithuanian Fish Farmers’ and Producers’ Association, a body that was originally envisaged as an association of pond farmers. For producers using recirculation
aquaculture systems, like Fish & Fish, there is also another association, Modern Aquaculture, of which the company is also a member. However, issues faced by pond farmers are sometimes the same as those faced by farmers using recirculation technology, says Mr Greviskis, but not always. For example, compensation for losses incurred by farmers due to the pandemic was calculated di erently depending on the method of production. Among the tasks of the association is to assist farmers in seeking compensation in such situations. Another is to organise generic promotion campaigns to encourage consumers to eat more Lithuanian freshwater sh. One eel-focused campaign appeared on national television and demonstrated ways to prepare the sh.
e company has another shop in a mall that has opened in a newly developed part of Vilnius. e area is full of residential apartments and to attract the residents the mall o ers attractions for children, so they can be occupied while a parent does the
A Fish & Fish store specialises in domestically farmed and processed freshwater products.
shopping. is brings people to the mall who may or may not buy anything, but it is important to have this tra c, Mr Greviskis says. Visitors tend to be most numerous over the weekends and so he ensures that the Fish & Fish shop is well-stocked with a wide assortment of products. Among them is the smoked eel llet, three pieces of which are sold in a packet for EUR 8. Customers that know and like the product will buy it without considering the price, but others may prefer cold smoked salmon, which is very well represented, or
perhaps cold smoked tuna. But it is in the fresh products that competition is particularly intense, Mr Greviskis remarks, as fresh eel must compete not only with other fresh sh but also with meat.
At the shop, Valdas Nariūnas, the manager, is busy building a market for the eel, informing customers how to use and how to prepare the sh. Five years ago there was no demand for small eels in Lithuania. Instead, the demand was for specimens a kilo and more in size. We really had to start from scratch, says Mr Greviskis, educating the customer. is meant o ering smokehouses the sh for them to smoke and hoping that its popularity would grow as people came to appreciate the product. Today the small eels are much more popular than the large sh, he says, but the interesting thing is that the sales of large eels has not diminished, but they have become a di erent product category from the small eels. is development explains why Fish
& Fish’s sales of large eels have increased slightly over the last ve years, while sales of small eels have risen sharply. e company’s sales are primarily through its shops, the Horeca sector, and other processors. It does not deal directly with supermarkets, but often customers for the frozen eel process it and sell the processed product through supermarkets.
Exporting smoked eels to other countries that are traditional consumers of this product is no easy task, as buyers for this specialised item are conservative and tend to want to stick to the product and the
Kaštonų g. 15, Skudutiškio k., Suginčių sen. 33322 Molėtų r. sav., Lithuania
Tel: +370 677 84705 martynas@eelfarm.eu www.fishfish.lt
Business Development Manager: Martynas Greviskis
Vice-chairman: Andrius Breive
supplier they have known probably for the last many years. Moreover, if o ered a copy of the product they have already, most buyers would rather stick with the original. Mr Greviskis thinks the answer lies in nding markets where smoked eel is a novelty and then educating potential buyers, just as was done in Lithuania. Building a market, however, is a long drawn out and expensive a air that could easily take 3-4 years. Despite this he is looking at Estonia and at an even more potentially interesting country, Poland, where the market is big and products using small eels remain to be discovered.
Production: 200-240 tonnes per year
Products: Live and gutted eel
Value added products: Smoked eel, smoked eel fillets, smoked eel in jelly, gutted and frozen eel, and frozen eel fillets

Markets: Lithuania, Netherlands
Customers: Shops, Horeca, processing companies
Own outlets: Mobile shop, specialised stores

ICECO Fish, a fish and seafood processing company, produces a range of products based on Norwegian salmon and herring that are exported to many parts of the world. It also has a range of products sold under its Zigmas brand that is well-known in Lithuania and the other Baltic States.
Lithuania hosts several companies that process sh and seafood for export markets. High quality, certi cation to international standards, proximity to raw material sources, salmon in particular, good logistics, and competitive labour costs are among the reasons that the volumes of sh and seafood processed in Lithuania have been increasing fairly steadily over the years. Among the companies that are contributing to this increase is ICECO Fish which, according to Lina Ruigiene, the Head of Sales, is one of the fastest-growing sh processing companies in the Baltic region. e company’s production activities date back to 1995 and today are broadly split into salmon, herring, and seafood and white sh. Sales of salmon products account for 70 of the total followed by herring with a fth.
e sh processing company is but one of the units in the ICECO Group. Other units include one that is responsible for self logistics and storage services as well as managing xed assets of the group. For delivery overseas the company uses external service providers or, in some cases, the client will organise the shipping. Another unit produces ice cream, and nally there is a trading unit which distributes both ICECO and other companies’ products,
manages ICECO own retail shops and outsources production of some Zigmas branded products.
Salmon is processed primarily into smoked products for export and salted products for the domestic market. A small fraction of the salmon is also frozen. Smoked products are both cold and hot smoked with a preponderance of the former. Other salmon products include marinated and dried, while cuts include llets, portions, and steaks. Like most continental salmon processors, ICECO Fish sources its sh in Norway, from where it arrives fresh on ice. e sh is not more than three days old from the time it is slaughtered and gutted, says Ms Ruigiene. On a typical day working a single 12-hour shift the company can process a truck of salmon or about 23 tonnes, though this depends on the orders received for the day. In summer the number of orders tends to go up and production is increased accordingly. Orders are received at least seven days in advance though there are some clients who plan campaigns in speci c periods and may place their order up to two months in advance. But seven days is the minimum we need to organise the raw material and negotiate
all the terms and conditions, says Ms Ruigiene. Aidanas Simokaitis, Head of the Quality Department, explains that after the sh arrives it is headed, cleaned, and then machine lleted. e llets are trimmed manually, however. All the waste, heads, backbones, trimmings are collected and sold for conversion into animal feed. e llets themselves have the pinbones removed and are also skinned if the nal product calls for it.

e processing is tailored to the client’s requirements. Skin on or skin o , the salting method, the
smoking time and temperature, and the packaging are all determined by the customer. Salting, for example, says Mr Simokaitis, can be dry salting, brine injection, or a combination of the two. e salt percentage and tenderness of the product is decided by the client and we follow those speci cations. After salting the llets are left to mature. However, the time to maturation is also decided by the client and can vary from 8 to 72 hours. Dry salting, for example, usually calls for a longer maturation period. If the nal product is a marinated llet a little sugar is added to the salt. Speci cations can come from the client, but the client may also ask the company to produce using the specications for one of ICECO’s own
branded products. e important thing is that we use skilled workers and can easily adapt the production to the demands of the client, Mr Simokaitis emphasises. Our technologists are used to managing many di erent recipes and we can manufacture from a small pilot production to a whole truck or more. While the production process can be carefully controlled, the quality of the nal product is largely in uenced by the raw material. ICECO Fish has a long history of working with Norwegian suppliers and has identi ed the packing stations where they can secure raw material of a high and consistent quality, and maintains a list of suppliers they can contract to deliver this product. Furthermore, each batch of the raw material arriving at the factory is tested by the company’s technologists who remove 100 sh from the consignment and check the quality, including colour, blood spots, fat content, texture, freshness etc. Production starts only after the technologists sign o on the quality. Nine-tenths of the raw material comes from ASC or GlobalG.A.P. certi ed sources and some is even certi ed to both standards.
e llets are smoked over beechwood chips and are subject to another round of cleaning and trimming where the brown meat is removed before being sliced and packaged in modi ed atmosphere (MAP) or vacuum. e lms can be different colours, thicknesses, and textures, and the trays too can be di erent colours. e company is also looking at more sustainable packaging as this is increasingly being demanded by clients. e nal product can be supplied chilled or frozen and the packaging whether laminate, sleeve or box can be printed on or have a label. For the domestic market ICECO Fish produces both under its own brand and for private label and supplies the largest retail chains in the Baltic.
According to Ms Ruigiene, the company is the leader on the domestic market by market share in the chilled processed sh category with the largest percentage share in smoked salmon.

e retail chains are important buyers, but the company also sells its products to shmongers
and the HoReCa sector. Clients often also decide the packaging speci cations and so the company has acquired the capacity to manufacture from 75 g packs and upwards.

While product speci cations are often supplied by the client, they are developed inhouse as well, sometimes in collaboration with a customer. Technologists develop and test recipes not only for taste, texture, mouth feel, and appearance, but also for shelf life, and behaviour under storage. ICECO Fish draws on expertise from, for example, the Kaunas University of Technology where necessary when developing the product. Ideas for new products re ect consumer demand for snacks and for ready-to-eat products that can be eaten straight from the packaging with minimal or even no preparation required. ese too will be subject to stringent quality control when they enter commercial production. Mr Simokaitis’
Packaging will gradually become more sustainableThe spike in energy prices prompted the company to invest in solar panels which now cover all the buildings and supply 20% of the energy requirements. Sales of salmon products account for 70% of the total by value. The salmon is sourced from Norway and is processed into a variety of added-value items.
department tastes samples from production batches on a regular basis to check the quality. If necessary, samples are sent to be tested in laboratories abroad. Even after the product is available for sale at the supermarket, samples are taken from the shelves to monitor how they are doing under those conditions. is also applies to
the herring products the company manufactures which are usually marinated or salted llets but can also be combined with spices, sauce and other condiments such as vegetables, seaweed, beans and even mixed together to create ready-to-eat meals and snacks. Some herring recipes go back 50 years and are highly sought after
Herring products are consumed on the domestic market but also in countries with sizeable numbers of people of Eastern European origin who tend to be familiar with the taste.
Hot smoked eel with an Asian flavour wins plaudits

ICECO’s Hot smoked European eel in soyginger sauce sold under the company’s Zigmas Fine Cut brand was a finalist at this year’s Seafood Expo Global Excellence Awards competition in Barcelona. The eel is sourced from the Netherlands and is smoked using beechwood chips at our factory in Marijampole, then flavoured with soy-ginger sauce and topped with sesame seeds, says Lina Ruigiene, the Head of Sales. It can be eaten alone, as a snack, or as a dish with condiments. Ms Ruigiene was naturally a bit dissatisfied that the product did not win but it got a lot of publicity and attracted visitors to the company stand at SEG who were keen to taste it. The skin packaging, tray, and label also won a number of compliments. The product is not yet for sale, however, for the idea was to gauge public response before committing to producing it. We now have an idea of the demand and will take a decision on whether to go further, she adds.
by customers. While herring products are mainly intended for the domestic market, they are also exported mainly to countries that host communities from Central and Eastern Europe, as they know and appreciate the product.

Increases in energy prices and general in ation a ected ICECO Fish in 2022, but it was worse in some months than in others. e end of year results, Ms Ruigiene notes, were more or less in line with the budget as the prices of both raw materials and energy
Factory and HQ: Ledo g. 1, Liepynai, Marijampoles sav., Lithuania
Administrative office: Karaliaus Mindaugo ave. 35, LT-44307 Kaunas, Lithuania
Tel: +370 343 92745 info@icecofish.com icecofish.com
Head of Sales: Lina Ruigiene Head of Quality Department: Aidanas Simokaitis
stabilized. e new salmon tax in Norway that is due to be imposed shortly adds some uncertainty regarding raw material prices. e hike in energy prices did nudge the company into making a major investment in solar panels in 2022, so that now all the buildings are covered by solar cells. e investment was supported by the government and some 20 of the company’s energy requirement is met from these panels. Other planned energy saving initiatives include a wind turbine and the recycling of heat generated by refrigeration and freezing equipment. e focus on sustainability is bound to stand the company in good stead in the years to come.
Activity: Salmon, herring, whitefish and seafood processing
Products: Smoked, marinated, salted salmon; marinated, salted herring

Product forms: Chilled, frozen
Packaging: MAP, vacuum, bag, skin, plastic box, buckets, jars
Brand: Zigmas
Export share of production: 75%
Customers: Retail chains on international and domestic markets
Certifications: IFS, GLOBALG.A.P., ASC, MSC, EURO EKO
The National Food and Veterinary Risk Assessment Institute (NFVRAI) is the assigned risk assessment institution in Lithuania providing scientific and technical assistance in the field of food safety and veterinary matters. It also functions as the national reference laboratory carrying out laboratory tests in the areas of food and feed safety, quality, and animal health (including aquatic animals). NFRVAI is a subordinate body of the State Food and Veterinary Service of the Republic of Lithuania.

Fish is a valuable source of nutrition and an essential component of the human diet. However, it is also prone to various risks and contaminants that pose potential health hazards. e NFVRAI plays a crucial role in assessing these risks. One of the primary responsibilities of the NFVRAI is conducting risk assessments related to sh health and shery products’ safety. is includes evaluating potential hazards such as viruses, bacteria, parasites, etc. pathogens in live sh and microbial contamination, chemical residues, and heavy metal concentrations in shery products. It also covers identi cation of sh species by DNA barcoding. By employing state-of-the-art laboratory techniques and scienti c methodologies, the institute identi es and quanti es these risks.
e veterinary risk assessment unit performs risk assessment on animal health, animal welfare, animal products, animal nutrition and feed safety. It also stores, organizes, analyses data and scienti c information, and provides scienti c and technical assistance to ensure feed
safety, animal health, and animal welfare. Under sh health the institute’s laboratories look for viruses, bacteria, and other diseases, as well as parasites that can a ect the main sh species in the country. Fish can be treated either as animals or as food. If the samples come from the market the target is often chemical residues or microbiological contamination, while if the samples are from the farms the tests are intended to uncover parasites or bacterial or viral infections. Five units—bacteriology, serology, virology, anatomy and histology, molecular biology and GMO—are involved in diagnosing infectious animal diseases. ese units have fully equipped laboratories capable of performing a variety of sophisticated tests.
e NFVRAI thus plays a signi cant role in monitoring and surveillance of sh-related risks. is enables the institute to monitor compliance with regulations, detect potential hazards, and helps the State and Food Veterinary Service to take appropriate actions to prevent the distribution of unsafe sh products. By actively engaging in surveillance activities, the NFVRAI acts as a safeguard against potential foodborne illnesses and protects the health of consumers.
e institute is currently implementing a project (Capacity building in aquaculture animal health and welfare) approved by the Ministry of Agriculture under which primarily sh farmers, and also sh enthusiasts who maintain a pond of sh for recreational purposes, can bring samples to the laboratory to be tested without having to pay for the tests. e project is part of an e ort to build capacity and competencies within sh health and welfare and is funded under the European Maritime and Fisheries
Fund 2014-2020 (EMFF). Fish welfare is a new area of focus for the EU Member States and a lot of e orts are going into this eld, says Darius Nienius, deputy director of NFVRAI. e project will contribute to the development of an aquaculture sector that is competitive, resilient, and sustainable and that promotes animal and human welfare, health, and safety. e project ticks several buttons in relation to the European Commission’s 2021 strategic guidelines for aquaculture including the need to reduce prescriptions of veterinary medicines and pharmaceuticals such as antimicrobial and antiparasitic substances through prevention (rather than cure) of
infections and infestations. It also addresses the lack of codes of good practice for the early detection, prevention and control of aquatic diseases not listed in relevant EU legislation and the need for more consistent and thorough investigation of aquatic diseases. In term of sh health and welfare the project will contribute to the dissemination and exchange of information and best practices regarding veterinary diseases in aquaculture and the appropriate use of veterinary medicines.
e project will facilitate an improvement in the epidemiological status on the sh farms and in the country as a whole, says Egidijus Pumputis, the director of NFVRAI. e message about the free-of-charge
testing is disseminated through the institute’s website and also through the state Food and Veterinary Service’s network of o ces around the country. An earlier part of the project completed in 2022 involved the purchase, installation, and validation of the equipment necessary to perform
the tests. is enhanced the institute’s diagnostic capabilities by a factor of 3 and also signi cantly increased the scope of tests performed and reduced the time to obtain results. In 2023 tests were carried out on sh and water samples taken from Lithuanian aquaculture farms for pathogens
and for physical and biochemical anomalies. In addition, the presence of chemical residues was also tested for. After the testing and diagnosis, the medicines and measures needed to treat the disease and prevent recurrences are covered by the farmers. e most common problems a ecting carps which remains the main farmed species in Lithuania (62 of total farmed and sold aquaculture production in 2022) are not only parasites and bacteria. For example, infections with carp edema virus cause serious problems for farmers. e role of NFVRAI in such a case is to test and con rm or deny the presence of the disease.
When testing samples, diagnosing, and recommending treatment the laboratory offers complete confidentiality. If the farmer knows that testing and treatment can be done discreetly thereby protecting their commercial interests, they are more likely to bring the fish to the laboratory to be tested when a disease is suspected. The

incidence of disease is not necessarily a reflection of poor farm management as diseases can be carried by birds or other natural vectors over which the farmer has no control. With the dissemination of information about the programme and the benefits it offers the institute has been getting calls from farmers seeking help. The programme also enables monitoring the farms more closely; rather than waiting until a disease is suspected, fish and water samples can be tested, say in the spring when pathogens typically increase, to try and prevent an outbreak. The freeof charge testing service will be offered for five years from 2023.
Climate change has in uenced patterns of disease on Lithuanian sh farms, says Mr Pumputis. But, in general, the impacts on sh farmers are less in this part of the world than in others. Good quality water, for example, is still available to farm sh. Diseases that a ect sh calls for specialised knowledge that many veterinarians do not have. ey are familiar with viral diseases that a ect sh, but for other kinds of diseases the institute is where the expertise lies. For disease prevention and management strategies farmers approach the institute for advice. Even for the institute identifying a disease is not straightforward as there could be di erent reasons behind sh falling ill. e problem may be in the water or may be caused by some other factor. In this regard the existence of data plays an important role. With its new equipment and the tests that it is carrying out the institute is gathering information that will help in diagnosis and treatment of sh diseases. Using the information we receive from the farmers we are creating an epidemiological
The ultra-high performance liquid chromatography-mass spectrometry (UHPLC-MS) system is used for rapid, sensitive, and accurate determination of a wide variety of chemical organic compounds such as pharmaceuticals, hormones, steroids, feed additives, etc. in sh and shery products (as well as in all other products of animal origin). It should be noted that this system detects minimal amounts or only traces of already known chemical substances, and also identi es unknown chemical compounds.

picture that will aid us in the future, Mr Pumputis states. To be able to help the aquaculture sector by enhancing public capacities and knowledge in this area was the main idea behind this project, says Loreta Brazinskaite from the Fisheries Department in the Ministry of Agriculture. Treating sh diseases is not always easy as the range of drugs that can be used is limited. Antibiotics against sh diseases are not always available so alternatives have to be found. e institute with its connections to other laboratories and research institutes in other countries is far better suited to nding these alternatives than sh farmers. Vaccination is not practiced in Lithuania at all, partly because of the expense, but also because there are legislative barriers. In addition, there may be negative reactions from the market, which producers do not want to risk.
rough its risk assessment, testing, surveillance, regulatory, and communication activities, the National Food and Veterinary Risk Assessment Institute in Lithuania works to mitigate risks associated with sh production, processing, and consumption.
By collaborating with industry professionals and governmental authorities, the NFVRAI helps establish and enforce standards that protect consumers and support the sustainable development of the aquaculture industry in Lithuania.
J. Kairiūkščio g. 10, LT-08409, Vilnius
Tel.: +370 52 78 0470 info@nmvrvi.lt https://nmvrvi.lt
Director: Egidijus Pumputis
Deputy director: Darius Nienius
Key activities: Laboratory analysis, risk assessment, scientific activities
Important partners: European Food Safety Authority (EFSA),
food safety authorities in Germany, France, Finland, Latvia, and other countries
Employees: 288 including veterinarians, chemical engineers, biologists, and microbiologists
Project (Capacity building in aquaculture animal health and welfare) value: EUR1.6m of which 96% was for laboratory equipment
EMFF support: 100%
African catfish farming has gained considerable attention and success in Eastern Europe in recent years. The introduction of this nonnative species, specifically, the African sharptooth catfish (Clarias gariepinus), has opened new avenues for aquaculture in the region.
The African cat sh is highly adaptable to di erent water conditions and exhibits rapid growth rates, making it well-suited for aquaculture. Its ability to tolerate a wide range of temperatures and water qualities has made it an attractive option for. Additionally, the cat sh has a robust feeding behaviour and can consume various feed types, including commercial pellets and locally available organic matter, reducing production costs.
Cat sh farming typically takes place in specially designed aquaculture facilities such as ponds, tanks, or recirculating systems. ese systems provide optimal water quality, temperature, and oxygen levels, ensuring the healthy growth and development of the cat sh. Farmers closely monitor the environmental parameters to maintain the ideal conditions for the sh. e sh has gained in popularity in Central and Eastern Europe due to its market value. It is highly regarded for its rm esh and mild avour which appeals to consumers. Catsh llets are versatile and can be used in various culinary preparations, further increasing demand for them in the market. Furthermore, African cat sh farming has provided economic opportunities by attracting investments and creating employment opportunities, particularly in rural areas where
alternative sources of income may be limited. e establishment of cat sh farms has stimulated local economies, contributing to the overall development of the region.
Juvenile output to increase by a factor of 12
e rapid growth, ability to tolerate high densities, and relative ease of culture have made the African cat sh a popular sh to farm in Lithuania. Production has increased steeply from 46 tonnes in 2014 to 893 tonnes in 2022, according to the Lithuanian Agricultural Data Center. Among the farmers producing this species is Vladas Vickūnas, the managing director of Akvapona. Mr Vickūnas has been farming cat sh for over a decade and has seen demand increase rapidly over the last couple of years. As a result, from 100,000 juveniles per year he now plans to grow out 1.2 million. is vast expansion has called for the construction of a new and larger facility which has been placed next to the older one on the production site in Skaisterių village just outside Vilnius. Inside the new building four larval tanks hold some 25,000 African cat sh larvae each. Between 20 and 40 of them will not survive here, says Mr Vickūnas, which is a reasonable mortality rate considering that in nature it would be about 99

that do not survive. Akvapona has its own broodstock for the production of eggs and sperm. e females are treated with hormones and then after about 12 hours the eggs are extracted. Depending on their size females can give up to 5 kg of eggs corresponding roughly to 5m in number. But for Akvapona’s purposes 800 g of eggs are enough, says Mr Vickūnas. Sperm is collected from the males with a syringe. Eggs can be harvested from the females every 3-6 months over a period of several years. e females currently used as broodstock are already 5-6 years old and some of them weigh more than 20 kg. But it is possible to use sh from the time they are a year old.
When cat sh farming rst started in Europe the original wild sh were brought from Africa. e wild sh were bred and subjected to selection for generations as the activity spread across the continent to create sh much more suited to being cultivated. Experience has taught Mr Vickūnas that the most eggs are produced when a male of Dutch origin is crossed with a female of Lithuanian or Latvian stock. e eggs hatch after 24 hours and the high fecundity means that the water in the tanks sometimes becomes opaque because of the larvae. e huge number of larvae brings its own challenges as it is more difcult to get the amount of feed right and not over- or underfeed.
African cat sh grow rapidly and are robust which has made them popular sh to farm in several countries.
For the rst 48 hours after hatching the larvae feed on the yolk sac, but thereafter they must be fed. Initially, Mr Vickūnas was using artemia, but then he found that a new feed developed by a Danish producer gave better results.

As the sh grow, they are graded and moved to larger tanks. Initially only a few sh are moved to make sure conditions in the new tanks are acceptable to the sh. If the initial group is thriving after three or four days then the rest of the batch is moved. In each batch about 1 are “shooters,” that is sh that grow many times faster than the others in the batch reaching 1.2 kg in the space of four months. ey are very aggressive and if they are not separated from their batchmates in time they will start to prey on them. Shooters can eat up to 40 of the smaller sh, says Mr Vickūnas, and must be placed in separate tanks within a few days of being identi ed. Although well known as a robust and fast-growing species African cat sh are also sensitive. Lights, sounds, and even scents can bother them. ey recognise people either from the timbre of their voices or, more likely, says
Mr Vickūnas, from their scent. Before the pandemic, the farm used to have groups of schoolchildren visiting, and Mr Vickūnas used to warn the accompanying teachers not to wear perfume as it disturbed the sh. ey are also not happy when the water is too clear. With high density and clear water, the sh can see each other and can start ghting. To prevent this a bit of sand and mud is mixed into the water to increase turbidity. When disturbed the sh dart around in the tank, while under normal circumstances the breeders will lie quietly at the bottom. As they grow the sh eat less and less as a proportion of their body weight. While the small ones put away 8 of their weight in feed, this fraction drops to less than 1 for the big sh.
e move to the new site is not quite complete as some machinery is waiting to be installed including the grading equipment. is machine can automatically grade sh from 7 g and upwards sorting them into di erent containers depending on their weight category. Smaller sh however are graded manually. Other systems will measure the parameters of the water and the data can be
monitored on a mobile phone app. e use of smart systems on the farm extend to the broodstock which have chips embedded in them. ese are injected with a pneumatic gun and encode data on the genetic provenance of the sh. is data can be accessed when the chip is scanned. is knowledge prevents undesired cross breeding and promotes desirable traits in the stock. e feeding system for the new tanks will also be upgraded to a pneumatic system that can scatter feed into the tanks so that all the sh can feed simultaneously. e old feeding system will be used instead in the hatchery. African cat sh require water at around 28 degrees so the water that is drawn from a well to feed the farm is heated by burning wood waste in winter and by heat pumps in summer. is year solar panels will be installed that will be used to heat the water though they will not cover more than 3 to 4 of the requirement in summer and nothing at all in winter. Mr Vickūnas is also experimenting with a bio oc in one of the sh tanks. is is the growth of benecial bacteria in the tanks that consume nitrogenous sh wastes and toxic metabolites and creating a protein-rich food source for the sh. Bacterial growth is fostered by maintaining a higher carbon to nitrogen ratio in the tank. e advantage of the bio oc is that the sh need less feed since they can feed on the bio oc. However,
Skaisterių str. 2C
Skaisterių village LT-13118 Vilniaus district Lithuania
Owner: Vladas Vickūnas
Activity: Catfish farming and processing
the environment in a tank with a bio oc need to be carefully monitored to ensure that all the parameters are within healthy limits. However, he cautions, he is still learning about the bio oc, and will extend the experiment to some more small tanks and try it out for a year before deciding whether it is worth it.
e sudden increase in demand and the need to expand the farm have a ected the company, which is running out of sh to sell. Fortunately, the summer is coming when demand is lower giving more space for the renovations and improvements. Next year capacity is expected to grow to 1,000 tonnes of which two-thirds will go to three big retail chains leaving some 300 tonnes for sale to smaller outlets such as shmongers and delicatessen shops including Akvapona’s own. We are also talking to potential buyers in other countries, says Mr Vickūnas, but I have deferred all commitments to after the New Year. e meaty taste of the sh makes it popular also in schools and kindergartens. And one of the most highly sought after products is cakes made from minced cat sh meat (70) and vegetables. Products like these are driving interest in sh among young and old alike and play an important role in a healthful and sustainable diet.
Volumes: 1,000 tonnes (2024)
Products: Headed fish, fillets with and without skin, portions, frozen fish cakes (14 varieties)
Markets: Lithuania
Customers: Supermarkets, fishmongers, delicatessen shops
A new international research project will use bacteria’s natural enemies, bacteriophages, to control bacterial diseases in aquaculture. The Innovation Fund Denmark has invested EUR 1.8 million in the project.
Aquaculture is the fastest growing industry in animal food production in the world and supports an increasing global demand for healthy food. Fish farming has a signi cantly lower climate footprint than other animal production, but disease in the larval and brood stages of sh constitutes a signi cant bottleneck in sh production and causes large economic losses in the industry. Fish fry cannot be vaccinated, and antibiotics are therefore often used in the treatment of diseases. is entails a risk of the development and transfer of antibiotic resistance, which partly reduces the e ectiveness of the treatment and partly increases the risk of the spread of antibiotic resistance to food and the environment.

In a project coordinated by Professor Mathias Middelboe, Department of Biology, University of Copenhagen, researchers from the University of Copenhagen and the Technical University of Denmark collaborates with the key biotech and aquaculture business Danish Technological Institute, DanAqua, KSK Aqua, Aller Aqua, Carus Animal Health and Fixed Phage to develop a new environmentally friendly technology for the treatment of bacterial diseases in trout
farming. e starting point for the project is to use the bacteria’s natural enemies, the bacteriophages, in the ght against pathogenic bacteria in aquaculture. e goal is that the project’s results can contribute to phasing out the use of antibiotics in the aquaculture industry and contribute to a sustainable development and restructuring of the sector, by preparing new products to the market.
e previous research into bacteriophage-based control of sh diseases by Professor Mathias Middelboe, his team and collaborators, has shown promising results in recent years, and now the Innovation Fund Denmark together with the English company Carus Animal Health and seven other Danish and British companies have invested 2.8 million Euro in taking the next step in the development of antimicrobial products that can reduce disease outbreaks in trout rearing.
Rainbow trout is one of the most important sh species produced in the EU (24 producer countries, >250.000 t produced per year with a value of >EUR660 million), accounting for ~30% of the global trout production. e increasing global demand for farmed sh for consumption represents a strong driver for the further expansion of the industry. However, an increase
in aquaculture production is constrained by the environmental concerns associated with eutrophication, antibiotic spillover etc. Further, a signi cant increase in disease outbreaks in rainbow trout farming during the past 15-20 years as a result of shifting production towards recirculating systems (RAS) has led to a >300% increase in the use of the broadspectrum antibiotic orfenicol reduced production e ciency.
A key barrier for expanding the aquaculture industry are therefore the environmental issues of antibiotic use, and discharge of waste and nutrient to the environment. erefore, directing the industry through a green transition by solving the challenges
related to disease issues is an absolute prerequisite for expanding the potential of aquaculture production in the future. e aim of the project is to develop and test one or more prototype phagebased products with documented antagonistic e ects against Flavobacterium psychrophilum for use in the prevention of Rainbow trout Fry Syndrome (RTFS) in rainbow trout RAS aquaculture systems. RTFS causes serious disease outbreaks in most rainbow trout hatcheries with mortalities of up to 80-90% if left untreated. e products are thought to be used preventively as feed supplements or applied to biological lters in recirculated breeding facilities. As the diseases in question are
globally widespread and have major negative consequences for the industry throughout the world, products that reduce sh mortality and support sustainable production have great commercial potential.
More speci cally, the expected outcomes of the project are
1) a database of a well-characterized collection of F. psychrophilum phages
2) an optimized production platform for F. psychrophilum phages for pilot scale production
3) safe and stable prophylactic applications of phages tested at farm and lab scale conditions
4) a development and approval plan for selected product types
5) a cost-bene t analysis including the economic and environmental e ects of the technology
6) a market analysis of the proposed phage-based products
7) a pipeline for the regulatory pathways for EU-wide market authorization
Contact: Professor Mathias Middelboe Marine Biology Section, Department of Biology, University of Copenhagen Strandpromenaden 5 3000 Helsingør Denmark
Facts: The Innovation Fund’s investment: DKK13.5m
Total budget: DKK20.7m
Duration: 3 years
Official title: AQUAPHAGE: Towards a sustainable aquaculture Novel solutions for disease prevention supporting the green transition in aquaculture production.
Technological Institute, DanAqua, KSK Aqua, Aller Aqua, Carus Animal Health, and Fixed Phage and will run for 3 years.
Five EU Missions, a new endeavour by the European Commission under the Horizon Europe research and innovation programme, seek to support Europe’s transition to a greener, healthier, more inclusive, and resilient continent.
With the EU Missions the Commission has launched a new way of bringing concrete solutions to some of the greatest challenges of our society. e Missions have ambitious goals and aim to deliver tangible results by 2030. By rethinking research and innovation in a new setup, and combining new forms of governance, interdisciplinary collaboration and citizen engagement, they aim to deliver impact in our communities. EU Missions are launched as part of the Horizon Europe research and innovation programme and is a new way of creating solutions to some of the greatest challenges.
e EU Mission Restore our Ocean and Waters (Mission Ocean) is one of ve EU Missions. e Mission Ocean and Waters aims to protect and restore the health of our ocean and waters through research and innovation, citizen engagement,

and blue investments. e Mission’s new approach will address the ocean and waters as one and play a key role in achieving climate neutrality and restoring nature.
e Mission Ocean and Waters does so by supporting the work
within three main objectives, which are:
• To protect and restore marine and freshwater ecosystems and biodiversity, in line with the EU Biodiversity Strategy 2030.
• To prevent and eliminate pollution of our ocean, seas and
waters, in line with the EU Action Plan Towards Zero Pollution for Air, Water, and Soil.
• To make the sustainable blue economy carbon-neutral and circular, in line with the proposed European Climate Law and the holistic vision
demonstrate, develop and deploy the Mission activities. By having a local, inclusive, and transformative objective, the Mission seeks to challenge fragmented and sectoral governance structures. is is done by mobilising actors, activities, tools and systems needed to collectively work towards reaching the Mission objectives and targets. In the lighthouse of the North Sea and Baltic Sea, the focus is on 1) making the sustainable blue economy carbonneutral and circular, to 2) eliminate greenhouse gas emissions from maritime economic activities in the EU and sequester those emissions that cannot be avoided (net zero maritime emissions), and 3) to develop zero-carbon and lowimpact aquaculture, and promote circular, low-carbon multi-purpose use of marine and water space.
In order to support the EU Mission Ocean and Waters locally, the Danish Ministry of Higher Education and Science has initiated a Danish hub, that collects all stakeholders working within the marine, maritime and freshwater themes. e hub will function as a network of stakeholders. A network that promotes the achievement of the Mission Ocean objectives across Denmark, the Faroe Islands, Greenland, and other relevant countries. Working together across sectors and organisations on the importance of protecting our ocean and waters, and how to do it together.

e Danish Mission Ocean hub will provide information on the purpose of the mission in a Danish, Faroese, Greenlandic, and general Nordic context. e hub will o er updates on the status and the Mission, information on upcoming calls and progress of the work programmes under Horizon Europe, learning from others’ experiences and inspiration from present projects. rough the hub, match-making opportunities that will support future partnerships of Mission Ocean projects will also be available. Furthermore, the hub will arrange workshops on subjects related to Mission Ocean, such as stakeholder and citizen engagement. By doing so the hub seeks to empower citizens and the young to take action and to share knowledge of the aquatic realm.
e Danish Ministry of Higher Education and Science invites all stakeholders with activities within the objectives of the EU Mission Ocean and Waters, to join the Mission network in Denmark. e next meeting of the Danish Mission Ocean hub will be in September 2023.
If you have any questions or are interested in joining the Mission Ocean and Waters hub, feel free to contact Niels Gøtke, Head of Division, EuroCenter, Danish Agency for Science, Technology and Innovation, nigoe@ufm.dk or Cecilie Petersen, Ocean Mission Manager, University of Southern Denmark, cep@sdu.dk
enshrined in the Sustainable Blue Economy Strategy.
e Mission seeks to bundle existing e orts at EU, national, regional, and local levels, together
with regional engagement and cooperation through an areabased approach, implementing “lighthouses” in major sea and river basins. e Mission lighthouses are sites to pilot, demonstrate, develop and deploy the Mission activities across EU seas and river basins. ese lighthouses act as pilots to


AlgaeProBANOS, a new €12 M EU-funded initiative, is spearheading the acceleration of innovative product development and market access for sustainable algae solutions in the Baltic and North Sea and beyond.
In recent years, there has been a growing interest in micro- and macroalgae in Europe as their role as alternative protein and other nutrient sources is immense. Various initiatives, such as the Algae Initiative, Ocean Mission BANOS lighthouse, and the engagement of European industry, consumers, and influencers, have highlighted the potential of this industry. Despite this, there are still several challenges that must be addressed to unlock the full potential of the algae industry, such as biomass supply, high production costs, limited knowledge of markets and consumers, limited knowledge of risks and impacts, and fragmented governance framework, among others.
AlgaeProBANOS (APB) brings together universities and research institutes with start-ups, SMEs and industry members as well as innovation, training and entrepreneurship experts, representing ten countries from across the Baltic and North Sea region with the shared goal of demonstrating market accessibility and presence of sustainable and innovative algae products and solutions in the Baltic and North Sea (BANOS) regions. e 26 partners bring a wealth of
expertise and resources to the table to support the objectives of Mission Ocean while positioning Europe’s algae industry to thrive.
e AlgaeProBANOS project, funded by the European Union’s Horizon Europe programme, will directly contribute to the Blue Mission BANOS lighthouse initiative, which engages and supports stakeholders across the Baltic and North Sea to reach a carbon-neutral and circular blue economy. e primary objective of AlgaeProBANOS in industrial processes is to establish a dependable and sustainable supply of algae biomass that meets the industry‘s quality and quantity standards, while simultaneously protecting the health of ocean ecosystems. In terms of economic development, APB aims to reinforce the appeal, resilience,
and e ciency of algae products, thereby reducing risks and attracting investments for scaling up. Furthermore, APB seeks to enhance the social acceptance and legitimacy of algae products, ensuring widespread adoption of these products and practices through social licenses. By achieving these objectives, APB endeavors to create a thriving and sustainable algae industry that bene ts both the environment and society at large.
During the 48-month project, AlgaeProBANOS will support six business cases to bring eight products to the market from sustainable and circular microand macroalgae sources. These products will target important markets such as food, aqua feed, cosmetics, nutraceuticals, textiles, agriculture, and many more.
As the EU algae sector expands, it is crucial to increase the sustainability, security, and quality control of algae supply while also addressing climate change. In 2019, only 0.8% of global production came from the EU, with 96% of it relying on wild harvest rather than cultivated methods commonly used in Asia. Current harvesting practices lack consideration for environmental impact, overharvesting prevention, and ecological damage mitigation. APB aims to tackle this challenge by developing an integrated monitoring strategy for wild harvest in the region and developing cultivation protocols for commercially viable macroalgae species
tailored to the environmental conditions of BANOS.
On the other hand, the microalgae industry in Europe is relatively small in comparison to the macroalgal sector, comprised of 400 companies producing 300 tonnes annually with the majority located in the southern regions of Europe. AlgaeProBANOS pilots are bringing microalgae production to the Baltic and North Sea region. Microalgal biomass nds applications in various sectors, including food, feed, nutraceuticals, cosmetics, fertilizers, and biostimulants. e market value of microalgaebased products is estimated to be around €500 million, and it is projected to rise to €900 million by 2030. However, there is a need for technical innovations to reduce capital expenditure and production costs in the industry.
It is important to note that the successful microalgae cultivation technologies employed in Southern Europe may not directly apply to the BANOS region due to climate and environmental conditions. To address this challenge, the AlgaeProBANOS project aims to bridge the gap and demonstrate the feasibility of two microalgae farms tailored to
the BANOS regions. A promising aspect of microalgae cultivation lies in its integration with waste streams, which can provide valuable CO2 and nutrient sources. By e ciently utilizing these waste streams, the microalgae industry can contribute to the principles of the circular bioeconomy and develop sustainable and regionspeci c solutions in the eld of algae-based industries.
In the dynamic algae market, business development tools can be overwhelming and unclear, hindering producers’ ability to grasp matchmaking and networking opportunities. is is particularly critical for fast-growing start-ups seeking connections with established companies along the value chain. To address this, AlgaeProBANOS will create diverse digital tools for farming, processing, product marketing and logistics. ese tools aim to enhance producers’ visibility, facilitate connection between farmers and processing companies, foster the development of raw material market, support consumers to navigate the products
o er as well as processing companies to discover new products and raw materials.




As part of the project, an Algae Business Club (ABC) will be formed. e ABC will serve as an exchange platform for industry partners and investors to share information and exploit AlgaeProBANOS outcomes. To ease interaction there will be an online matchmaking tool.
With the aim of designing services and products that align better with users’ needs and provide insightful information to innovators and entrepreneurs, ultimately leading to more socially and economically sustainable solutions, AlgaeProBANOS will carry out co-creation workshops. ese multi-stakeholder workshops will cover ideation, experimentation, and validation involving endusers, consumers, and industry experts. e project will also organize interactive algae journeys in speci c cities to increase public awareness and collect feedback on algae products.


To accelerate the development of new products and markets, the project will develop replicable go-to-market strategies and blueprints useful to algae entrepreneurs, and socio-economic assessments for policymakers. In line with this and to drive innovation within the algae sector, AlgaeProBANOS will support third-party start-ups and SMEs that are developing products and services that can bene t and speed up the technology and market uptake through third-party (cascade) nancing for mentoring and coaching. Selected cases will have access to mentoring and
advice on technical, business, legal, or marketing matters via the SUBMARINER Network Accelerator that since 2017 has mentored 40+ technology business cases.
AlgaeProBANOS partners gathered on 15, 16, and 17 of May 2023 in Berlin, Germany to set the stage for the exciting journey ahead. e event was hosted by SUBMARINER Network, the project‘s leading partner. e meeting provided a platform for the 26 project partners to know each other, align visions, unveil the project’s overarching strategy, and establish clear objectives. Speaking at the project launch, Angela SchultzZehden, Managing Director of the SUBMARINER Network, said she was excited to be embarking on this new Baltic and North Sea lighthouse project which is among the largest EU-funded algae projects. Only a decade ago, the cultivation and use of algae in Europe was very much at the research stage. Today, many largescale industry players are highly interested in algae as a new bioresource to improve the environmental footprint of their products. AlgaeProBANOS will make a big contribution to mainstreaming the use of algae in very di erent industries throughout Europe, making it an everyday commodity for future generations.
e next major meeting will be at the 1st Mission Ocean Arena in Gothenburg Sweden on 14, 15, and 16 November 2023, where a wide range of stakeholders will meet and discuss, with the aim to get inspired by critical innovation solutions and start transferring them to their regions to make an impact.
For more information, contact:
Ferdinand Bulmer fbu@submariner-network.euLevan Kantaria manages seafood operations for the premium food retailer WineTime, headquartered in Kyiv. Mr Kantaria was born in Kyiv and studied law at the Humanitarian University of Tbilisi. He then worked in distribution at SAVSERVICE and four years ago, he switched to his current role managing the fish and seafood operations at Asnova’s WineTime subsidiary. In this article, he discusses the challenges the company has been facing in wartime. This is the second in a series of articles in the Eurofish Magazine dedicated to seafood businesses in Ukraine and how they work and survive during the war.
The rst WineTime retail shop opened thirteen years ago, and today the company owns 33 shops across 15 regions of Ukraine, cumulatively employing over four hundred people. e stores sell a wide range of premium food products, including seafood. e company also has a separate farm, named Trostynka, that raises cows, sheep, and goats, and grows organic vegetables. ey also run a bakery. Some of their store location have their own food courts with chefs who can take anything from the shop’s shelves—from sh to sausages—and cook it for their clientele. Fourteen of their locations have what the company has named “sushi-points,” where there is a sushi kitchen in the shop. Eight of their stores have fresh sh counters and about twenty sell oysters. Eight years ago, WineTime opened a web-shop o ering a wide range of products.
Alcohol represents about 60% of the company’s turnover, and the remaining 40% is comprised primarily of gastronomy. Most of the sh sold in their shops is imported from all over the world. e supply of local sh depends upon the areas open to shing during the war. Currently, the main locally sourced species are Danube shad and, occasionally, carp.

Many Ukrainian consumers consider buying sh to be an impulse purchase. WineTime’s attractive fresh sh counters with a colourful variety of sh and seafood play a major role in sales. Knowledgeable shop-assistants, who can inform customers about where the sh comes from, how to cook it, and which garnish accompanies it best, have encouraged sh sales.
Mr Kantaria claims his company is number one in Ukraine for several reasons. ere are many similar chains that have more shops than we do, he says, but our level of expertise and service is second to none. One may say that eight shops with fresh sh counters is not a lot, but every shop assistant working at the counter is an educated expert. We have various types of sh on our counters from Label Rouge salmon, trout, tuna, sh loins, and llets to a variety of exotic sh. Our shop assistants will tell you what is good about each sh, where it originates, whether it is wild or farmed, what the fat content is, or whether it is good for your children. ey can advise you on the best cooking method and wine pairing. Not many chains can provide such a comprehensive service—at most
you will hear if the sh is fresh or not. Our shop assistants get performance reviews on a regular basis, and not many other stores which sell sh can o er such a high level of expertise, he adds.
WineTime’s online store mainly o ers canned sh, salted and smoked sh products, and caviar. e company’s team hopes that one day they will be able to sell fresh sh online, but demand is currently quite limited. e company hopes that this will change, and that increasing trust in the quality of WineTime’s products will help to e ect this change.
Since the beginning of the war in February 2022, supply chains have been disrupted. ough even before the war transport of sh by air was limited, the war has now made it impossible. ese days everything is carried by road in trucks, but even these deliveries were paused for some time in the beginning. ere are not many seafood importers in Ukraine and some of these companies supply restaurants and had deliveries every week.
Despite the most challenging odds Levan Kantaria has managed to maintain the supply of fish and seafood to consumers in cities across Ukraine.e restaurant business was badly a ected by the war, so the importers started delivering once every two weeks. e importers who supply mass markets, including big retail chains and smaller chains like WineTime, maintain weekly deliveries, and supply primarily farmed sh such as Norwegian salmon and trout, Turkish seabass, sea bream, and trout.
Before the pandemic, WineTime was ranked in the top three oyster retailers in Ukraine, but Covid was a “punch in the gut,” says Mr Kantaria. At the beginning of the war, sales dropped even more,
as oysters are not an essential product according to government guidelines. Besides, most oysterlovers either ed abroad or went o to war, he says.
During the rst few months of the war, the costs for Ukrainian consumers rose dramatically due to high import prices. Many foreign suppliers were afraid to go even as far as to Poland, and there was an enormous food de cit. A partner in Latvia was one of the rst to o er WineTime a helping hand. In March 2022, when the situation on the front was very uncertain and many were fearful of Kyiv’s invasion, the company
provided a deferred payment system and supplied canned sh. At the time Kyivans were living in fear—some left the city, and those who did not ee were stockpiling. e shelves at the stores were left bare. ankfully, the supply chain slowly began to recover and now it has almost returned to normal in terms of both availability of products and sales revenues.
When the war began, Mr Kantaria explains, we had to stop our normal work, but our shops remained open. From the very rst days we reorganised our corporate café into a volunteer kitchen, and we started giving food to the defenders, rescue services, and the Armed Forces of Ukraine (commonly known as ZSU). Every day the kitchen prepared one thousand meals which were made from the company’s own products. Dennis Galushko, the café’s director, organised and lead the volunteer kitchen. When Russian troops were kicked out of Kyiv Region, Mr Galushko, a father of three, joined the Azov Brigade and lost his life in combat. In the company’s headquarters there is a memorial wall with photographs of him and his colleagues who lost their lives in the war.
All the pro ts made by one of the wine brands that WineTime distributes are directed exclusively towards car purchases for the army. To date, four cars have been purchased and donated to ZSU. Not only WineTime, but all companies of Asnova Holding are actively involved in volunteer activities. Mr Kantaria himself participates in volunteer projects in addition to WineTime’s e orts. He was personally awarded with a medal by Ukraine’s minister of defence for his activities.
e situation was exceedingly di cult in autumn 2022, when Russia started to destroy critical Ukrainian infrastructure, destroying the power supply in many cities all over Ukraine. WineTime purchased power generators and Starlinks and invited people to the stores, o ering them a space to work, charge their phones, enjoy some tea, and spend time in a space with light and heat.
The WineTime store located in the city centre of Zaporizhzhia was completely destroyed by a Russian missile. Luckily, the attack took place during the night when there were no people inside. The shop’s employees were offered jobs in other stores of the chain, and those who agreed to re-locate to other cities are now working and WineTime pays for their housing.

In spite of these di culties, the company continues to expand: recently a new store in Uzhgorod opened, and soon there will be another opening in Rivne. ere are also plans to open stores elsewhere in Europe. ese are very di cult times, says Mr Kantaria, but we are saving workplaces for our people. We are developing and, as of today, we are one of the most stable companies, paying wages on time and providing workplaces. Our business and volunteer jobs are equally important to us. Mr Kantaria told Euro sh much more about sh, business, volunteering, and the war. roughout the interaction, his love for his job, family, his fellow citizens, and for Ukraine was abundantly clear.
Aleksandra Petersen, aleksandra@euro sh.dk

As in almost all aquaculture systems, there is also a latent threat of disease outbreaks in trout farms, which brings with it considerable risks for fish populations and thus threaten the economic success of the company. To prevent such problems, welfare-oriented animal husbandry and proactive health management play a vital role. Good professional practice and compliance with legal duty of monitoring are essential.
AWorld Bank-commissioned study in 2014 put the annual economic losses in global aquaculture due to disease outbreaks at around USD6 billion. An extremely cautious and certainly far too low estimate, especially since the “farm gate value” of world aquaculture has increased since 2014 from USD160 billion to USD282 billion (2020) according to FAO. is gure overlooks the nancial losses and reductions in growth from parasites like sea lice, something that salmon and salmon trout farms have to spend hundreds of millions of dollars every year to control. Disease outbreaks reduce animal welfare, and the necessary treatments bring
about enormous costs. ey represent a constant challenge for aquaculture operations, for which there is no easy solution in most cases. For sh farmers, farm managers, and sh veterinarians, preventing disease outbreaks is crucial for the success and sustainability of their operations. It is important to develop e ective management strategies and implement tools that can help mitigate the risks of diseases and limit their consequences. Disease prevention and management are critical for the success of all types of aquaculture, including trout farming.
Almost all living beings are naturally susceptible to parasite
infestation, pathogenic germs, and fungal infections. In aquaculture, this is particularly true for sh that are reared in intensive farming environments. Under such conditions, the high stocking densities can increase stress and exacerbate the spread of diseases. at is why proactive health management is particularly important in intensive breeding. e water quality and the health status of the sh must be constantly monitored. Quarantine for newly arriving stocking sh would be an e ective measure to prevent the introduction of diseases into aquaculture farms, however, it may not always be possible due to space limitations.
In Europe at least, the aquaculture sector is strictly regulated by law, and many management decisions do not solely lie in the hands of sh farmers. ere are detailed regulations for environmental, water and consumer protection, and animal health is monitored by regular veterinary checks. e abundance of rules and regulations in aquaculture can help to ensure high production standards. However, for sh farmers who are less legally savvy, it can be di cult to keep track of the regulations. To make matters worse, some data
As healthy as a fish in water? In open systems from the pond to the net pen, trout are always exposed to many environmental health hazards.are collected multiple times and by di erent administrative levels. Aquaculture operations are subject to approval and require a permit under water law. ey are also subject to accounting obligations resulting from various laws and regulations. ese include food, animal health and pharmaceutical legislation. Compliance with all of these obligations is monitored as part of o cial operational controls.
An important focus of the inspections is the health and welfare of the sh. Trout can be a ected by a number of bacterial and viral pathogens and parasites, creating particular vulnerabilities in both freshwater and marine environments where salmon trout, like salmon, are reared in

net pens. Sea lice, for example, have become a major problem for marine salmonid cultures.
ese parasitic copepods eat the skin and blood of salmon and trout, causing lesions that can lead to secondary infections.
e producing countries have now switched to far-reaching health management measures, since direct control measures are expensive, time-consuming and rarely lead to lasting success. Both national and regional biosecurity plans aim to reduce the sea lice problem. ese measures include, for example, the spatial and temporal separation of the sh stock in individual areas, more e ective controls of transporting the equipment and personnel within and between the farms, the thorough disinfection
of the equipment used and the observance of rest periods between restocking of the net enclosures. In combination with drug-based sea lice control campaigns, which are subject to strict regulations and are usually carried out by veterinarians, the problem should be limited and, if possible, suppressed. However, biosecurity plans also prevent the spread of many other diseases.
e risk of disease outbreaks is particularly high in open waters because the sh are constantly exposed to potential external pressure from pathogens. It is di cult to control sudden changes in water quality that a ect the resistance

of the sh to disease. e cause of a disease outbreak is often not a virus, a bacterium, a parasite or a fungus alone, but is usually a co-infection in combination with environmental stressors. Infectious diseases often break out when the sh are under constant stress due to inadequate environmental conditions, suboptimal husbandry practices and poor hygiene. is weakens their immune system and makes them susceptible to pathogenic germs. e combination of virulent pathogens, a vulnerable host animal, and adverse environmental conditions creates ideal conditions for diseases to spread rapidly if they are not caught early and treated. Unlike in open waters, the water quality can be in uenced to a limited extent in many trout farms and thus diseases can


profiair OxyTwist 750 – also known as paddlewheel aerator –sets new standards in the aeration.


Sets new standards in the aeration of production ponds, spa garden ponds, and sewage treatment plants. Apart from oxygenation and gas exchange, profiair OxyTwist 750 with its 2 paddlewheels will create water current.
profiair OxyTwist 750 improves the water’s quality measurably and visibly, and significantly reduces algal growth. Due to the water quality improvement realized by profiair OxyTwist 750, it contributes to increased yields from your production ponds.
profiair OxyTwist 750 is delivered as assembly kit.

be prevented. In this context, the temperature and the oxygen content in the water are of particular importance. ese master factors must always play a central role in preventive biosecurity and health management.
Examples from trout farms in Baden-Württemberg show how important a good oxygen supply is. By aerating the sh tanks with pure oxygen, not only could the water volume be used optimally, the water quality improved, the stocking densities increased and thus the pro tability of the farms increased, but the health and resistance of the trout to the Aeromonas and Pseudomonas bacteria was also signi cantly strengthened. Since then, furunculosis has almost completely disappeared.
Vaccines, which stimulate a strong protective immune response against certain pathogens, are also
gaining importance as a management tool in the toolbox of disease prevention. Such vaccines already play a certain role in marine salmon trout farming, but they are still largely irrelevant in freshwater. is is probably also due to the fact that there are hardly any commercial vaccines available for trout farming. In addition, they are sometimes controversial in the industry and not approved everywhere. Nevertheless, immunization by vaccination could be an important and promising future preventive approach that belongs in the “ rst line of defence” of disease management. In addition, vaccinations are better than reacting to the outbreak of a disease with chemicals or even antibiotics.
We’ve come a long way with the use of functional feeds and some alternative products that boost the immune system of sh whilst improving their resistance to stress and disease. e range of products in this area are now so diverse and extensive that it is often di cult to separate
scienti cally proven and e ective remedies from dubious alternatives that probably only serve to increase the bank accounts of their providers. Since there are undeniable links between chronic stress, weakened immunity and increased susceptibility to disease, a lucrative market is opening up for products that are designed to elicit physiological responses that could improve the overall health status of sh. Probiotics that are added to the feed that reduce bacterial loads or increase host resistance are widely used. Prebiotics in the feed promote a healthy microbial ora and so-called postbiotics, which contain antimicrobial peptides or polysaccharides, act against bacterial pathogens. Various herbs and spices and their derivatives are said to have similar health-promoting properties. But how do you properly assess the health and welfare of trout? Are there any objective criteria that provide reliable information on this subject? Absolutely – and for free even! For example, a 130-page manual in English and Norwegian
has been available to download on the No ma website since 2020. is handbook allows trout farmers to assess the welfare of their sh using “indicator toolboxes”.
On April 21, 2021, Regulation EU 2016/429 (Animal Health Law) came into force. is replaced the Directive 2006/88/EC, which previously regulated the obligations of European trout farmers. e new regulation aims to harmonize the principles of disease monitoring and control throughout Europe and to make them clearer, streamline content and clarify ambiguities. e new Animal Health Law, which regulates almost everything from the export of horses, goats and deer to the border crossing of carrier pigeons, has been ambitiously adopted, but this resulted in a bureaucratic monster that is di cult to understand and leaves many questions in practice. Producers and exporters of “aquatic animals”, which include crustaceans and molluscs in addition to sh, have to tediously search text after text just nd the legal requirements and obligations that apply to them. Luckily, relatively little has changed for sh and trout farmers. Most farms, from the hatchery to the fattening facility, must continue to meet the high standards of biosecurity that have existed up to now. All activities of parties involved must be aimed at preventing the spread of sh diseases at the national and international level.
e obligation to keep records of incoming and outgoing sh stocks remains in place, as does the obligation to report animal transports. For the transport of sh within the EU, TRACES certi cates must be issued by the

competent veterinary authorities. e electronic database system TRACES (Trade Control and Expert System) was set up throughout the whole of the EU on the basis of the Decision 2003/623/EC42. e obligation to notify and report particularly dangerous sh diseases, which form the basis for government preventive and control measures, also remains in place. In the case of trout and other salmonids, this applies in particular to listeriosis and salmonellosis, ISA, EHN, IHN, and VHS. Registered and licensed aquaculture companies are required to keep records of unusually high mortality rates in trout stocks. If an increased mortality rate is found that cannot be clearly attributed to certain husbandry or transport conditions, this must be reported to the competent authority immediately.
Despite all caution, disease outbreaks can occur even in wellmanaged trout farms. Early recognition of symptoms and rapid action is important to prevent damage to sh stocks and limit economic losses. In order to be able to initiate the necessary measures, every sh farmer should have a basic knowledge of the most common diseases, how to identify them and immediately treat them. An extensive arsenal of clearly illustrated specialist literature is also available to support them, showing the characteristic features and damage symptoms of the diseases. As a result, in cases of an outbreak of any disease, initial assumptions of its nature can be drawn, its precise determination by a specialist veterinarian be completed and the necessary therapeutic treatments initiated. Prescribing and use of medication
is strictly regulated in almost all trout farming countries and is also usually carried out under the supervision of a veterinarian. In principle, only drugs that are approved for the disease to be treated may be used in EU countries. All these measures ensure that treatments are e ective and safe for the sh, the environment, and consumers. In order to be able to guarantee consumer safety, the prescribed waiting times between treatment and later harvesting for commercial use must be observed. Every single step in this package of measures must be meticulously documented. Obligations to provide evidence of the use of pharmaceuticals for edible sh result from the Drugs Act, the Food Hygiene Ordinance and the water law permit. Fish farmers must provide evidence of the purchase of veterinary prescription medicines (e.g. prescription, invoice or delivery note) and must record their use. At the same time, the veterinarian must also provide corresponding evidence of their prescriptions as a sort of cross-check.
e manufacture, use, and monitoring of veterinary medicinal products is regulated by the EU Code for Animal Medicines, which is supplemented by additional regulations in member states. However, in aquaculture there is a limited number of medicines that are speci cally approved for use in sh. e limited number of approved medicines for use in sh farming has been a cause for concern, with critics warning of a “therapy emergency” in the event of a disease outbreak. e use of disinfectants in aquaculture can be comparably complicated due to the limited number of approved disinfectants. Some active
Salmon trout, called “fjord trout” in Norway, spend part of their lives in the sea, like salmon, where they are exposed to marine pathogens and parasites.
substances, such as malachite green, copper sulphate, or potassium permanganate, are no longer permitted in the EU. Even the use of lime for pond disinfection requires prior approval and must be used in prescribed concentrations to prevent it from entering other bodies of water.
Finally, a few words about the situation in recirculation systems, or RAS. As such systems are essentially isolated from the outside world, operators and the general public frequently assume that RAS are disease-resistant and safe. However, practice indicates that this is not always the case. In fact, circulatory systems have particularly favourable conditions for the emergence of illnesses and the multiplication of opportunistic microbes. High stocking densities, along with poor water quality, can promote the emergence of non-infectious illnesses.
Ammonia, nitrite, carbon dioxide, suspended solids, and ozone levels in circulation systems have already resulted in sh losses. Pathogen-related illnesses have also been observed in RAS rainbow trout. Bacterial (bacterial gill disease, furunculosis, bacterial kidney disease, n rot) and viral (IPN, VHS, IHN) infections are common. Occasional reports of parasites (Gyrodactylus, Chilodonella, Trichodina, Epistylis, Trichophrya, Ichthyophthirius) and fungi (Saprolegnia) have been recorded. e cause of these diseases is often the introduction of already infected stocking material and poor sta hygiene. Chemotherapy is extremely di cult in circulatory systems because there is always a risk of a ecting the bacteria in the bio lter. Consequently, e ective health management is critical to the success of these facilities and all other trout farms.
 Manfred Klinkhardt
Manfred Klinkhardt

e workshop was held in response to a request by the Department of Fisheries ailand. Its aim was to enable customs o cers and sheries o cers to identify parts of sharks and rays before permitting the trade of such goods at ai ports. About 50 participants from the Marine Fisheries Research and Development Division, and Fish Quarantine and Fishing Vessels Inspection Division, attended the workshop.
e training was led by Dr Haji Ahmad bin Ali, Southeast Asian Fisheries Development Center, Malaysia; and supported by Mr Tassapon Krajangdara and Mr Opas Chamason, Marine Fisheries Research and Development Division, Department of Fisheries, ailand. e topics included the taxonomy of sharks and rays recorded in ailand and the species listed in CITES Appendix I and Appendix II;
the biology of sharks and rays recorded in ailand; products of sharks and rays listed in CITES found in ailand’s markets; and an identi cation guide to fresh and dried sharks and rays listed under CITES at sheries landing sites. In the practical session, participants were guided and trained on the external and
is publication, developed by the Food and Agriculture Organization of the United Nations (FAO), with the active support of the World Customs Organization (WCO), builds on the Harmonized System: Nomenclature 2022 edition. It presents all possible classi cations for sheries and aquaculture products by species, with a full description of each HS code, to facilitate its use within the sheries sector, including aquaculture. is publication does not modify the structure of the HS or modify species grouping, as it is an auxiliary tool to facilitate classi cation and enhance understanding of the HS system from the angle of sheries and aquaculture products.
is publication is divided into three sections: (1) the rst section presents all species which are directly referenced in the HS, with commodity codes for all possible classi cations of their products and treatments; (2) the second section lists all HS codes for sheries and aquaculture products with an exhaustive and comprehensive description of each code; and (3) the third section is a new section of the HS Handbook, where photos of the most
internal morphology of fresh sharks and rays listed in CITES; photographic techniques for taxonomy used for important external parts of fresh sharks and rays listed in CITES; as well as on classi cation of sharks and rays listed in CITES according to order, family, genus, and species.
commercially important species are shown. Each image contains relevant information and singularities of each species – scienti c name, FAO names, main characteristics, and distribution. e booklet can be freely downloaded
from https://scanmail.trustwave.com/?c=766 1&d=8uOl5B8R8RcSqN6FUmlyndRnAz2abOS qO169uay3wA&u=https%3a%2f%2fwww%2efa o%2eorg%2fdocuments%2fcard%2fen%2fc%2f cc6347en

GLOBALG.A.P. (Good Agricultural Practice) is the world’s leading farm assurance program. The organization provides certi cations to fruit and vegetable, oriculture, and aquaculture farms that meet its standards for safe agricultural practice. The purpose of the certi cations is to ensure that producers’ practices are safe and responsible while also creating transparency for consumers.
The organization started to provide certi cations to aquaculture producers in 2004, which was a species-speci c standard for salmon at that time, and today o ers certi cations to sh farmers in countries all over the world and for all aquatic species, whether these are n sh, crustaceans, molluscs or algae. For this industry speci cally, GLOBALG.A.P. only provides certi cations to producers whose practices are certi able throughout the entire supply chain. is means that a producer’s sh can only be certi ed if they are fed with sh feed that is also certi ed.
e organization was founded in the late 1990s in response to food security issues, particularly in relation to fruits and vegetables. It originated as a group of food retailers who worked in collaboration to manage the risks associated with the insecurities they were facing at the time. According to Remko Oosterveld, Key Account Manager, the organization has developed a lot since then. GLOBALG.A.P. currently works to regulate all sorts of farming practices, and they manage these farming
practices throughout the entire production process to ensure that they are safe and responsible. Mr. Oosterveld stated that in 2004, the organization became involved with the sh industry when it introduced a standard for aquaculture. e standard sets at every stage of the aquaculture production a high threshhold for best animal welfare practices. e terms of the standard were not just implemented for good practice, but also because of the organization’s ethical duty to prevent and combat animal cruelty – that is why animal welfare is deeply embedded in the company DNA. GLOBALG.A.P. aims to provide transparency through the entire production process, from start to nish, and there is growing interest from retailers to provide their customers with this transparency as consumers become, for example, more climate conscious.
Certi cation is useful to producers because it opens new markets and actively helps them comply with supply chain requirements and makes their products more appealing to many customers. To achieve certi cation the GLOBALG.A.P. standards are written in a clear and detailed manner that are used as a tool by producers to be their managers in all aspects by the holistic approach of the standard,
explained Mr. Oosterveld. e organization helps their clients to improve these issues as they have connections throughout the supply chain that their clients often do not possess.
e organization has both an aquaculture standard and a feed standard. e former covers the hatcheries, nurseries, and growout of sh farms while the feed standard covers the production
of the feed which fuels the larvae, juveniles, and sh. e organization follows the chain of custody until the nal stages of production in sh farms to ensure that there is no mixing or contamination with any uncerti ed products. e organization’s obligatory feed standard is unique and has been active since 2010. GLOBALG.A.P. currently covers the most important aquatic species in Europe, with a large percentage of the main aquaculture production volume certi ed, according to Mr Oosterveld. GLOBALG.A.P.,
is a cost-e ective solution for retailers, which chie y explains the company’s dominance of the aquaculture certi cation market. Many Eastern European producers do not have certi cation due to their small size, but several have begun to demonstrate an interest in certi cation. To increase accessibility, the organization also o ers group certi cation which is more cost e ective and might make certi cation for smaller sh farms more feasible. What is complicated about working with smaller producers, though, according to Mr. Oosterveld, is the need for collaboration throughout the chain of production. e organization designed their group certi cation process to promote collaboration throughout the supply chain so that, even while working with smaller producers, from feed production to nurseries, the entire process can obtain certi cation.
An important part of the organization’s work is to communicate with stakeholders and inform consumers about the meaning of the certi cation. To do this, the organization has spent time considering the e ectiveness of the GGN label used to signify certication and o er more transparency for consumers. In 2021, the organization introduced a universal label to be used for all their certi cations that replaced the individual logos for aquaculture, oriculture, and fruit and vegetables. Mr. Oosterveld explained that they did this to promote their recognizability. eir new GGN label is an illustration of a magnifying glass representing transparency as well as a farmer denoting the process of production rather than just the nal product itself being the scope of certi cation. e idea here is that each production step is clear, understandable and also comprehensible
for the end consumer, says Mr. Oosterveld. e GGN Label is combined with a numeric code which consumers can type into the organization’s website (ggn. org) to learn more about the product’s production. e new logo will be available to use on products from over 200,000 producers across all areas of certi cation. e consumer recognition that stemmed from the consolidation of the logo has had very positive impacts on GLOBALG.A.P.’s popularity and recognizability throughout Europe, says Mr. Oosterveld.
e costs associated with GLOBALG.A.P. certi cation consist of three elements, the certi cation fee, costs for the implementation, and costs for the certi cation. e GLOBALG.A.P. certi cation fee itself is extremely cost-e ective and is only a fraction of the total costs. e cost for the implementation of certi cation consists of sta responsible for quality assurance, establishing protocols, sta trainings, etc. e nal cost of certi cation is linked to the actual certi cation performed by an independent certication body. Costs associated with this are linked to a daily fee and travel expenses. Mr. Oosterveld explained that the total cost of certi cation is a limitation for certain, often smaller, producers. Although it is hard to know exactly the direct bene ts that the certication has on a producer’s sales and success, experience from certi ed producers indicates that it opens new markets and supports a robust management.
One of GLOBALG.A.P.´s core values is to be innovative, cost e cient, and o er transparent solutions, allowing safe and
responsible grown food around the globe. e organization makes its own revenue by way of its certi cation fee, the various trainings that it provides, and the GGN label.
During the Covid pandemic, as transportation came to a halt, GLOBALG.A.P. developed new rules which enabled them to introduce remote audits. Remote audit allowed the issuing of a new certi cate, but an on-site audit was required within the 6-12 months following the certi cation. Currently, there are only on-site
audits and certi cations, but there was much that the organization learned from providing remote audits which would be useful if introducing a remote option for certi cation and auditing in the future. Because auditing is a time-consuming job that requires extensive travel, o ering a remote option may create space for auditors to visit and work with more clients in a shorter period. Increased e ciency will bene t clients as well and should ultimately lead to more sustainability and greater transparency for all the links in the aquaculture value chain.
Nora Goodman, Euro sh, nora@euro sh.dk
GLOBALG.A.P. c/o FoodPLUS GmbH Spichernstr. 55 50672 Cologne, Germany
Tel.: +49 221 57776 -0
Fax: +49 221 57776 -1999
www.globalgap.org info@globalgap.org
Key Account Manager: Remko Oosterveld
Certification: Provides certifications to producers who adhere to safe, responsible, and transparent production practices

Types: Certifications for fruit and vegetables, floriculture, and aquaculture products
Location: Cologne, Germany
Markets: Certifications in 135 countries
Raisioaqua, Finland’s only fish feed factory, now operates as Alltech Fennoaqua Oy

Fish production in Finland is thriving as Finland‘s only fish feed factory operates under a new name reflecting its new ownership. The company formerly known as Raisioaqua is now operating as Alltech Fennoaqua Oy.
The company, which was previously owned by the Raisio Group, was recently acquired by Finnforel Oy and Alltech, an animal nutrition company headquartered in Nicholasville, Kentucky, USA. e new name, Alltech Fennoaqua Oy, is a reference to the company’s home country of Finland and the region around the Baltic Sea.
Alltech Fennoaqua ensures Finnish domestic aquaculture production grown from its domestic feed production in Raisio, Finland. Before the acquisition by Alltech and Finnforel, sh feed production in Finland was under threat. If the factory had shut down, Finland’s rainbow trout would have been entirely dependent on foreign feed. „Fish feed production could have stopped in Finland without this change of ownership,” said Tomi Kantola, CEO of Alltech Fennoaqua. “After that, one could have questioned whether sh raised in Finland could actually be called Finnish in the end. Now, Alltech Fennoaqua will continue to provide Finnish feed for sh raised by Finns.“
Fish feed is a core business of the new owners of Alltech Fennoaqua, who are pioneers in nutrition for sh in recirculating aquaculture systems (RAS). e volume of production at the Alltech Fennoaqua
factory will increase to accommodate additional production of RAS feeds. Alltech Coppens, Alltech’s aquaculture nutrition company, will also support the company through its RAS farming contacts and aid in developing new sales channels around the world for the feed produced within Finland. RAS farming is the future, according to Mr Kantola. Alltech Coppens has a research centre in the Netherlands, which can now be used in the feed company’s own research activities. anks to the research centre and the available capacity we can expand our production to include feeds used in RAS farming, he says.
Along with these ample resources for research and product development, the new ownership
will also enable the expansion of the company’s operations abroad. Alltech Fennoaqua‘s primary focus is on increasing exports, and thanks to Alltech Coppens’ global distribution, the company will be able to begin exporting feed to a much broader market, with a focus on neighbouring countries and regions, including Sweden, Poland, the Baltic countries, Lithuania, Latvia and Estonia. Alltech Fennoaqua will continue to develop, manufacture and sell sh feed in accordance with the principles of sustainable development and the circular economy, which align with Alltech’s purpose of Working Together for a Planet of Plenty™. e company’s focus is on producing feed that provides the highest level of nutrition, which bene ts the sh and, as a result, the end consumer. Nutrition is the most signi cant factor in the growth of sh, notes Mr Kantola.
e future is bright for the Finnish aquaculture industry, as Finns like eating sh—and are particularly interested in eating sh from Finland. Currently, one-third of the sh eaten by Finns is produced domestically. e average Finnish person eats 12.5 kilos of sh per year, with 4.2 kilos being domestic and 8.3 kilos being foreign. Domestic sh is fresh, healthy and, of course, tasty, says Mr Kantola, and the production of domestic sh feed ensures that Finnish sh can be grown if the import of foreign sh or sh feed is interrupted. With more than 80 of Finns reporting that they would like to increase their sh consumption, Alltech Fennoaqua is perfectly positioned to continue growing, both domestically and abroad.
For more information, visit alltech. com and alltechcoppens.com.
SAIREMmicrowave and radio frequency solutions—each have their own strengths
Frozen products can be tempered in many ways. A French company, SAIREM, specialises in microwaves and radio frequency technologies to gently and rapidly temper frozen fish and seafood.
The sh processing industry must often deal with frozen products. As a highly perishable product sh is often frozen to preserve quality if it cannot be processed immediately or when it needs to be transported long distances. Products are also frozen because the logistics for frozen goods are far easier than those for fresh. Products may also be frozen to meet the requirements of the end consumer. e demand for frozen sh has resulted in the development of an entire industry related to freezing.
And just as products need to be frozen, they also need to be defrosted, for which, too, there are a variety of techniques. awing, however, is a relatively complex process. While freezing is about reaching the target temperature as quickly as possible, thawing calls for the consideration of many more factors if the desired end result is to be obtained. Tempering procedures fall broadly under two categories. ose where the thermal energy to defrost the product is provided from the outside such as water, steam, or heated air, so that the product thaws from the outside inwards. In the second category the energy supplied generates heat directly within the product,
so that it thaws on the inside and the outside at the same time. is is characteristic of thawing systems using microwaves, radio frequency or electric current.
Traditional thawing methods, such as room temperature thawing or using warm water, can be time-consuming and may result in uneven thawing, compromising the taste and texture of the sh. Radio frequency (RF) and microwaves are electromagnetic waves that have proven to be valuable in various industrial applications. eir ability to generate heat rapidly and uniformly makes them ideal for tempering frozen foods, including sh. When RF or microwaves are applied to frozen sh, they penetrate the food, causing the water molecules within to vibrate. is vibration generates heat, which results in a controlled and even tempering process.

One of the signi cant advantages of using RF and microwaves for sh tempering is the reduced thawing time. Compared to traditional methods, these technologies can thaw sh in a fraction of the time, ensuring faster preparation and reducing waiting times in processing companies, commercial kitchens, or restaurants.
is time-saving feature is particularly bene cial for establishments that deal with a high volume of frozen sh products. Furthermore, RF and microwaves o er improved tempering uniformity. With traditional methods, thawing sh can often result in uneven temperature distribution, leading to portions of the sh becoming partially cooked or over-thawed. In contrast, RF and microwaves provide consistent and controlled heating, eliminating the risk of overcooking while maintaining the desired texture
and moisture content of the sh. As RF and microwaves can penetrate non-metallic materials, they can be used to defrost frozen products directly in their packaging such as in EPS boxes, cartons, or plastic bags.
e use of RF and microwaves for sh thawing also o ers enhanced food safety. Unlike conventional thawing methods, which may require leaving the sh at room temperature for an extended period, RF and microwaves thaw sh quickly, minimizing the time
during which bacteria can multiply. is reduces the risk of foodborne illnesses associated with slow thawing. e speed at which they can thaw products allows just-in-time production using frozen raw material. Moreover, RF and microwave thawing methods are energy e cient. ese technologies convert electrical energy into heat directly within the food, resulting in minimal energy wastage. Additionally, their rapid thawing capabilities reduce overall energy consumption compared to conventional methods. e space occupied by this equipment is also proportionately less than that required by conventional thawing systems using air or water.
ere are thus several advantages associated with the use of radio frequency and microwaves to thaw products. e possibilities they o er has encouraged a French company, SAIREM to create thawing systems to democratise the RF and microwave technologies. Unlike conventional thawing methods RF and microwaves defrost the product evenly throughout its volume. e di erence between the two is that they operate at different frequencies, says Mathieu Deschamps, the company’s export manager, so we can o er our customers the system best suited for their purpose.
SAIREM has di erent business units and supplies its machines to a wide range of industries from chemical, to rubber or wood drying, to stone breaking. Universities and research centres are customers for its laboratory models. Plasma machines are used in the production of synthetic diamonds, and nally there is the food sector where machines are used to temper and defrost food products, cooking, heating, pasteurisation, drying and sanitisation. In the tempering application, the temperature is increased from -20 or -10 to -1 (or less) degrees C. With tempering there is no weight loss, and all the characteristics of the food are preserved, yet the product can still be worked with. After tempering a block of shrimp, for example, the product is not completely thawed yet each shrimp can be taken individually from the block. Energy consumption when bringing a product close to 0 degrees C is less than when going above this temperature. And then it takes just 5-10 minutes to temper the product.
Food safety is an important business area for the SAIREM equipment which can, for example, pasteurise ready meals or ingredients, cook or dry, eliminate insects from cereals, eliminate bacteria such as salmonella or listeria.


Because RF and microwaves treat the food so gently, they are particularly suited to delicate products like sh and seafood. Mathieu Deschamps, the export manager, says one of the main advantages of RF and microwaves is the time they take: 5-10 minutes. A traditional defrosting room will take much longer, perhaps a day or two, to thaw the same product. e payback time for an RF or microwave machine is short because when tempering a product there is no drip loss— the weight of the block before and after the tempering is the same— and the temperature is homogeneous throughout the block. In a conventional system the product will show temperature differences and there will be some drip loss which adds to the cost. According to Mr Deschamps, the payback period is typically 6-12 months for SAIREM equipment. Energy costs are relatively low, the machines run on electricity, which is more cost e ective than gas, he says. And thanks to the gentle and uniform treatment the product maintains its taste, texture, colour, nutrients, and organoleptic properties. Microwaves are the best for homogenous warming, better even than RF, and they work well on irregularly shaped products. On the
other hand, to get the best results from RF, the products should have a regular shape such as a block. Even though this technology is several times slower than microwaves and the machines have a bigger footprint, the power e ciency is lower in an RF machine and today this is a major consideration for companies.
SAIREM is the only company that o ers both technologies. Most food applications today use microwaves while RF is used mainly in non-food applications, says Mr Deschamps, in the textile industry, for example, or for the drying of ceramics, wood, or cigars.
e only food application that lends itself to RF is the tempering of standard sh blocks to around -3 degrees C. For other sh and seafood—prawns, scallops, IQF sh—microwave is the preferred technology.
Food is not the biggest application in SAIREM’s portfolio, but it has grown steadily since the company took a strategic decision to focus on this area. The number of employees and the turnover have increased significantly. Machines for decontamination and food drying for example are selling more and more. SAIREM has an R&D centre where new solutions are developed and where customers can send their frozen products to be tested to see what kind of solution, microwave, or RF, and at which frequency, defrosts best. For tempering blocks, for example, a microwave at 915 MHz is most suited. In the case of ready meals, which are smaller, the frequency used is
2,450 MHz. The wavelength influences the depth of penetration which determines the most suitable frequency (as wavelength and frequency are inversely proportional to each other). One machine cannot however generate waves of different frequencies. While the company has a wide range of
standard machines it also customises its equipment to meet the specific needs of its customers. As consumption of fish and seafood increases around the world, so will the need for efficient tempering solutions as well as cooking and pasteurisation of ready meals with fish and seafood.
SAIREM
82 rue Elisée Reclus 69150 Décines-Charpieu France
Tel.: +33 4 72 01 81 60 welcome@sairem.com www.sairem.com
Export Manager: Mathieu Deschamps
Products: Batch and tunnels solutions with radio frequency or microwave, generators, etc
Function: Heat treatment for different applications and products
Markets: 70 countries around the world
Cretel makes food processing equipment as well as washing and drying systems for various sectors of the food industry. Their food systems are designed to process beef, fish and pork products. The washing and drying systems are deployed in industries including dairy, meat, poultry, fruits and vegetables, confectionary, and pharmaceuticals. The aim is to assist and enhance the work of producers while ensuring that important health and safety criteria are met.
ABelgian company that manufactures all of its technology in house Cretel, a part of the ATS Group, has been creating food processing technology and washing and drying equipment for fty years. e company has just released a new generation of its automatic sh skinner that minimizes waste, promotes safety and hygiene, and is designed to be cleaned with ease.
e company’s food processing equipment for sh includes sh skinners, sh scalers, vacuum packers, and pin bone removers. At the 2023 Seafood Expo Global, Guy Persyn, the company’s division manager, talked about the new product releases that the company had launched within the last year. e tabletop skinner and

the standalone, manual skinner were improved in a variety of ways. And last year, Cretel relaunched its automatic skinner. e company is generally cautious when designing new models, says Mr Persyn, because it wanted to ensure that only the aspects of their technology that could be improved were changed. Our customers know that they can depend on our products for twenty to thirty years, so we wanted to ensure our new machines were just as reliable and had the same longevity, he says. At the company they often say that their customers “aren’t just buying these machines for themselves, they’re buying them for their grandchildren.” e reliability of the company’s products is one of the characteristics most valued by its customers, so when developing the new skinner models, caution was taken to ensure the machine was as robust as its predecessor.
Mr Persyn explained that compared to Cretel’s original models, the company’s new sh skinners show increases in capacity, hygiene, functionality, and cleanability. e F460A, for example, was designed with easy use in mind. e new model allows for easy adjustment of thickness for
silver, regular, and deep sh skinning. And, its design prioritizes safety and simple maintenance, making it very user friendly. During the redesigning process, engineers improved the hygiene of the skinners by introducing a new surface treatment which minimizes bacteria on the skinners. e idea
behind this development was to encourage and assist sh producers in adhering to sanitation and health standards and protocols. e improved cleanability enables even the inside parts of the machine to be cleaned without any di cult handling. e new machine is equipped to skin any kind of sh such as carp, salmon, tilapia, perch, bream, herring, pike, and snapper.
The link with ATS offers wide-ranging benefits
Reliability is a trait associated with all Cretel products. e parent company, ATS Group, is a multidisciplinary technology group which acquired Cretel in 2005. All of our technology is made inhouse under ATS, which helps to explain the consistency in our technology’s longevity, says Mr Persyn. Products from the other business line, the production of large-scale washing and drying systems, are sold to a wide variety of industries, including the sh industry. ese products include
di erent systems of washers and dryers which are made speci cally for the crates, bins, containers, and racks that are used by the sh processing industry. e company o ers these products in di erent sizes and speci cations to cater to the needs of di erent sorts of shing and processing companies. Cretel’s customers produce all sorts of sh and the equipment is designed to work well with a variety of sh species. e engineering technology that the company has access to through its relationship with ATS enables Cretel systems to go beyond just washing and drying. For example, the tuna waste washing system involves machines which wash large containers in a tunnel washer. ese are then stacked by machine and nally automatically stored in a warehouse. Another example is a special robot that can adjust racks for pallets and containers and then places them in the washing machine. When the clean containers come out of the washing system, the robot begins to ll them again. Finally, there is also a
spin dryer which thoroughly dries the containers, after which robots transport them to conveyor belts. All of the company’s technologies, including the robots, are developed and made in-house, emphasized Mr Persyn.

Mr Persyn also commented on the impacts that the current global setting has had on the company. Even with Covid, the current geopolitical
Langerbruggekaai 15
9000 Ghent, Belgium Tel: +32 9 376 95 95 info@cretel.com www.cretel.com
Division Manager Mechatronics: Guy Persyn
Products: Fish processing equipment (fish skinner,
situation, and in ation, both the costs and sales of their machines have remained quite stable. e company sells its machines primarily in Europe, but they are also sold in Asia and in various parts of North America. e ability to sell products was largely una ected by Covid or any of the other recent crises even considering the vast global span of the company’s customers. e most notable impact has been the availability of spare parts. In the past, this was not an issue but as a result of the recent geopolitical crisis, Mr. Persyn says that their inventory of spare parts is less reliable. e problem with spare parts is that customers often wait to buy them until they are needed immediately, leaving the company with very little time to prepare for their customers’ needs. In years past, customers have depended upon Cretel for the spare parts they might need, often waiting until they became available through Cretel. But there is also a limit to customers’ patience and so also instances where they have turned elsewhere. e lack of spare parts is not as pronounced as it was at the start of the pandemic and Mr Persyn is optimistic that as the geopolitical situation continues to stabilize, the availability of spare parts will improve further.
Nora Goodman, Euro sh, nora@euro sh.dkfish scaler, pinbone remover) Washing and drying systems (tunnel washers, cabin washers, rack and trolley washers, industrial drying systems)
Production: Belgium
Markets: Europe, Asia, North America

The Mediterranean Action Plan of the UN Environment Programme (UNEP/MAP) was established in 1975 as a multilateral environmental collaboration framework in the context of the UNEP Regional Seas. Mediterranean countries and the European Community approved MAP to address common challenges of marine environmental degradation. Under the auspices of UNEP/MAP, the Convention for the Protection of the Marine Environment and the Coastal Region of the Mediterranean—known as the Barcelona Convention—was adopted in 1995. UNEP/MAP and the Contracting Parties to the Barcelona Convention—21 Mediterranean countries and the European Union—have progressively built a uniquely comprehensive institutional, legal, and implementing framework integrating essential building blocks for sustainability in the Mediterranean.
Tatjana Hema is the Coordinator of the Mediterranean Action Plan of the UN Environment Programme. An Albanian national, Ms Hema worked in the National Environment Agency of Albania and served as Deputy Minister of Environment before joining the UN. She played different roles in the MAP Barcelona Convention Secretariat including that of Deputy Coordinator until her appointment as Coordinator. Here she describes the workings of the UNEP/MAP-Barcelona Convention system and some of its achievements.
e contracting parties to the Barcelona Convention currently are 21 Mediterranean countries and the European Union. What bene ts do these countries derive from their membership of the convention?
When they voluntarily became Contracting Parties to the Barcelona Convention, the 21 countries and the European Union e ectively took on legally binding obligations to protect marine and coastal ecosystems in the Mediterranean in a concerted fashion. In doing so, they put aside their di erences, showed a remarkable sense of solidarity and focused on what mattered then and still matters now: addressing transboundary environmental challenges that, if left unchecked, could have devastated the Mediterranean region’s marine and coastal ecosystems. So, if we look at this in terms of benets, I would point to the invaluable dividends that the current and next generations derive from healthy marine and coastal ecosystems
that keep the Mediterranean Sea and coast alive and thriving. Bene ts go beyond the fact that natural systems underpin important Blue Economy sectors. e Mediterranean Sea is essential to the economies, livelihoods and lifestyles of peoples living around its rim. For millennia, it has shaped the civilisations that rose on its shores and continues to be a fundamental part of what it means to be Mediterranean.
How can the convention contribute to protecting marine and coastal habitats and threatened species and monitoring the spread of invasive species?
is issue is regulated by the Protocol Concerning Specially Protected Areas and Biological Diversity in the Mediterranean (SPA/BD Protocol) to the Barcelona Convention, which promotes the identi cation, designation, and e ective management of marine and coastal protected areas, including
habitats which are in danger of disappearing and/or crucial to the survival, reproduction and recovery of endangered, threatened or endemic species of ora or fauna. e Protocol emphasizes the conservation and restoration of habitats such as seagrass beds, coralligenous assemblages, dark habitats, and wetlands, which are vital for the survival of various species. e SPA/BD Protocol also includes provisions to prevent, control and eradicate invasive species. It promotes measures like early detection and response systems, risk assessments, and the development of management strategies to prevent the introduction and spread of invasive species in marine and coastal areas.
e UNEP/MAP-Barcelona Convention system has achieved
several notable successes since its inception in 1975, including the development of a regional action plan on marine litter and a protocol to prevent pollution from land-based sources. e convention has also helped to raise awareness about environmental issues in the region and promote international cooperation. What do you consider the major achievements of the Barcelona Convention since its establishment?
UNEP/MAP has gone a long way since its inception in 1975. It has made substantive contributions to the environment and development agenda in the Mediterranean region. Achievements are numerous and come in many forms: institutional, regulatory, technical... and include
capacity-building, monitoring and assessment, as well as the development and implementation of adequate policies covering the marine and coastal environment.

ank you for mentioning the Regional Action Plan on Marine Litter Management. We at UNEP/ MAP are proud of the fact that the rst legally binding regional framework addressing marine litter was adopted in the Mediterranean. Since it covers plastic and microplastic pollution, this is also an achievement that ongoing negotiations on a global treaty on plastic pollution is referring to, with States pointing to the need to draw on lessons learned from its implementation in the Mediterranean. Another major achievement: in December last year the International Maritime Organization’s
(IMO) Marine Environment Protection Committee adopted the Mediterranean Sea Emission Control Area for Sulphur Oxides and Particulate Matter (Med SOx ECA). is breakthrough is the upshot of a successful multilateral process stewarded by UNEP/MAP, which saw the Contracting Parties to the Barcelona Convention forge consensus and submit a coordinated proposal to IMO. Allow me to mention another achievement: the introduction of the Integrated Coastal Zone Management Protocol to the Barcelona Convention in Madrid in 2008. is was a rst, not just in the Mediterranean, but also on the international level. e ICZM Protocol still serves as a model for other regional seas around the world. On the biodiversity front, the rising numbers of loggerhead sea turtles in the
Mediterranean mean that our work in the eld of protection and conservation alongside our partners is bearing fruit. By the way, the emblematic Caretta caretta (loggerhead sea turtle) adorned the logo chosen for the 22nd Meeting of the Contracting Parties to the Barcelona Convention, which was held in Antalya, Türkiye, in December 2021.
e Barcelona Convention has seven protocols. One of the most recently adopted is the Protocol on Integrated Coastal Zone Management in the Mediterranean. is Protocol provides the legal framework for the integrated management of the Mediterranean coastal zone. Under the Protocol, Parties are called to take the necessary measures to strengthen regional cooperation to meet the objectives of integrated coastal zone management. What measures are to be taken and what results are expected?
Article 7 of the ICZM Protocol stipulates that Parties should collaborate to enhance the e ectiveness of coastal strategies, plans, and programs through joint consultative bodies or decision-making procedures. Close institutional coordination between relevant authorities at the national, regional, and local levels is strongly advised for both marine and land aspects of coastal zones. Furthermore, Article 28 of the ICZM Protocol emphasizes the importance of transboundary cooperation for contiguous coastal areas, in order to develop a coherent approach to tackle the main environmental challenges we are facing today.
By strengthening regional cooperation, we can achieve the sustainable use of natural resources, preserve coastal ecosystems
and landscapes, and mitigate the impacts of climate changerelated hazards. is also helps align public and private initiatives with decisions impacting coastal zone utilization. To full the objectives of the UNEP/ MAP-Barcelona Convention system and achieve Good Environmental Status (GES) of the Mediterranean Sea and coast, it is crucial to conduct awarenessraising activities, develop educational programs, and provide training on integrated coastal zone management. Only by fostering understanding and engagement we can ensure the sustainable development of our coastal regions and preserve them for the bene t of current and future generations.
Climate change is a major concern for the Mediterranean region, which is experiencing rising sea levels, increasing temperatures, and more frequent extreme weather events. What initiatives have been taken by the convention to mitigate the impacts of these changes in the countries in the region?
One of our main contributions in addressing climate change and its impacts in the Mediterranean is bolstering the regional knowledge base. e UNEP/MAP-Barcelona Convention system supports the network of Mediterranean Experts on Climate and Environmental Change (MedECC), an independent group of 700 scientists providing evidence grounded in science to underpin sound decision-making. UNEP/MAP also supports the Contracting Parties to the Barcelona Convention in developing local plans for adaptation to climate change. ese plans are based on Integrated Coastal Zone Management and are drawn up in a participatory manner involving all stakeholders.
UNEP/MAP and its Regional Activity Centres PAP/RAC (based in Croatia) and Plan Bleu (based in France) have been implementing Global Environment Facility (GEF) initiatives addressing climate change, including the MedPartnership and the MedProgramme since 2005. Key achievements include the development and adoption of the Regional Climate Change Adaptation Framework by all Mediterranean countries, vulnerability assessments conducted in Croatia and Tunisia, and the creation of several methodological documents on various aspects of climate change adaptation. I believe that our mandate would bene t from further strengthening the climate dimension. is is already re ected in the UNEP/ MAP Medium-Term Strategy (2022-2027).
UNEP/MAP cooperate closely with other platforms and initiatives as well as with international organizations such as the European Union to coordinate e orts to protect the Mediterranean environment. e institution also collaborates with civil society organizations, the private sector, and local communities to promote sustainable development. Can you provide some examples of projects involving these partners that have bene ted the environment in the region?
Although UNEP/MAP was at some point the sole actor in the Mediterranean region, it has always been open to partnerships with a view to optimizing regional governance. UNEP/MAP was the rst institution in the region to build a forum such as the Mediterranean Commission on Sustainable Development—the MCSD—, which is an inclusive forum for partnerships aimed at achieving
sustainable development in the region. e MCSD is unique in its composition and includes not only government representatives but also local authorities, socio-economic actors, non-governmental organizations, intergovernmental organizations, the scienti c community and parliamentarians. All MCSD members participate in its deliberations on an equal footing.
UNEP/MAP works with a network of “MAP Partners”, including NGOs and IGOs sharing our vision for the marine and coastal environment and sustainable development in the Mediterranean region. We have also built a strong partnership with the Union for the Mediterranean, and with several UN entities, global Multilateral Environmental Agreements, as well as international and regional organizations. UNEP/MAP is equally committed to implementing the agendas of our partners in line with our mandate and the decisions of the Contracting Parties. Voluntary contributions in the context of bilateral agreements with Contracting Parties support the UNEP/MAP Programme of Work. We have bilateral agreements with France and Italy.
Joining forces with partners, UNEP/MAP has built the MedProgramme, a 43 million USD assortment of eight child projects funded by the GEF with more than 100 coordinated actions at regional and national levels in the 2020-2024 period. And within the framework of the European Union partnership with UNEP, UNEP/MAP is implementing three projects funded by the EU and addressing marine litter, biodiversity conservation and protected areas, and the implementation of the Ecosystem Approach in the Mediterranean.
22-24 August 2023
Aqua Nor Trondheim, Norway Tel.: +47 73 56 86 40 post@nor-fishing.no https://aquanor.no/en/
14-15 September 2023
9th Fish Congress
Sopot, Poland
Tel.: +48 58 620 56 59 kongres@mprfish.com www.kongresrybny.pl
23-25 August 2023
SIFCE
Shanghai, China Tel.: +86 21 6127 6560 fine.wang@ite-gehua.com http://www.ffb2b.com/en/
31 August- 1 September 2023
6th International Carp Conference
Szarvas, Hungary bekefi.emese@magyarhal.hu https://carpconferencehungary.com/
18-21 September 2023
Aquaculture Europe * Vienna, Austria mario@marevent.com www.aquaeas.org
10-12 October 2023
DanFish * Aalborg, Denmark

Tel.: +45 99 35 55 18 ehe@akkc.dk www.danfish.com
5-7 September 2023
Global Shrimp Forum Utrecht, Netherlands www.shrimp-forum.com
27-29 September 2023
XXVIII National Conference of Carp Breeders Kazimierz Dolny, Poland biuro@ptryb.pl
https://www.ptryb.pl/index.php/844-karpiowka-2023
12-15 December 2023
AlgaEurope * Prague, Czechia

Tel.: +31 85 401 73 97 info@dlg-benelux.com https://algaeurope.org/
11-13 September 2023
Seafood Expo Asia

Singapore
Tel.: +1 207 842 5590 sales-asia@seafoodexpo.com www.seafoodexpo.com/asia/
3-5 October 2023
Conxemar *
Vigo, Spain
Tel.: +34 986 433351 conxemar@conxemar.com
https://conxemar.com/es/feria-conxemar-2023
25-27 February 2024
fish international * Bremen, Germany
Tel.: + 49 421 3505 260 fishinternational.de info@fishinternational.de
* Eurofish will be attending
Publisher Euro sh International Organisation
H.C. Andersens Boulevard 44-46
DK-1553 Copenhagen V Denmark
Tel.: +45 333 777 55, info@euro sh.dk euro sh.dk
Managing editor Marco Frederiksen
Editorial offices Behnan Thomas (bt)
H.C. Andersens Boulevard 44-46
DK-1553 Copenhagen V Denmark
Tel.: +45 333 777 64 behnan.thomas@euro sh.dk
Dr. Manfred Klinkhardt (mk) Redaktionsbüro Delbrück Franz-Stock-Straße 23
D-33129 Delbrück Germany
Tel.: +49 5250 933416 manfred.klinkhardt@web.de
Technical layout Thomas Jensen
Advertising AVW Marco Preuss Marderstieg 7a

D-21717 Fredenbeck Germany
Tel.: +49 4149 7570 avw.preuss@gmx.de
Aleksandra Petersen
Euro sh Magazine
H.C. Andersens Boulevard 44-46
DK-1553 Copenhagen V Denmark
Tel.: +45 333 777 63 aleksandra.petersen@euro sh.dk

Frequency 6 issues per year
Circulation 2500 copies + 5000 online readers

Subscription details Price: EUR 100,–To subscribe send an email to info@euro sh.dk
Unless otherwise stated, the copyright for articles in this magazine is vested in the publisher. Articles may not be reproduced without written permission from the copyright holders. A soft copy is available on request to aleksandra.petersen@euro sh.dk
ISSN 1868-5943

Order your free trial info@eurofish.dk

Insulated containers

You Can Count On!
Pioneers in production of insulated plastic containers

Pelagic fish processing
Nobbingmachines andAuto-packers forsardineandmackerel
VredenburgSouthAfrica
Mobile: +27 83 2620362
E-mail: easycancc@gmail.com

Website: www.easycan.co.za

Polystyrene compressors
A/S
The specialist in fishbox compactors and recycling Tel. +45 97371799
runi@runi.dk www.runi.dk
Thermal conditioning
ONE OF THE MAIN MANUFACTURES OF PROCESSING MACHINES FOR BIG, SMALL AND VERY SMALL PELAGIC FISH

Nobbing down to 110 pcs/kg
Filleting down to 100 pcs/kg
Up to 450 fish pockets per min
Slånbärsv.4, SE-386 90 Öland Sweden
info@seac.se WWW. SEAC.SE
Slicers
A different
kettle of fish
Collect a free copy from the Eurofish stand, 102-103, at Aquaculture Europe in Vienna, 18-21 September 2023


SALMCO Technik GmbH
Robert-Koch-Straße 19
D-22851 Hamburg-Norderstedt
Tel.: +49 40 7131472
Fax: +49 40 71370166
info@salmco.com
www.salmco.com





